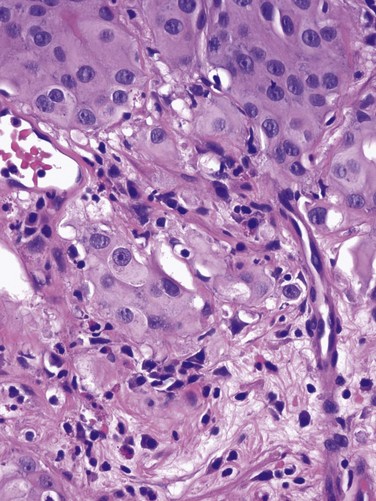
image

chapter 81 Non–Muscle-Invasive Bladder Cancer (Ta, T1, and CIS)
Traditionally known as superficial bladder cancer, malignant urothelial tumors that have not invaded the detrusor are more appropriately termed non–muscle invasive (Epstein et al, 1998; Smith et al, 1999). The former term suggested that all such tumors shared the relatively benign course of low-grade papillary tumors, giving misleading reassurance to patients with the highly malignant subcategories of carcinoma in situ (CIS) and high-grade Ta and T1 lesions. Approximately 70% are non–muscle invasive at presentation. Of these, 70% present as stage Ta, 20% as T1, and 10% as CIS (Fig. 81–1) (Ro et al, 1992).

Figure 81–1 Carcinoma in situ is a high-grade, flat malignancy confined to the urothelium. Papillary tumors confined to the urothelium are Ta, whereas papillary tumors invading lamina propria are T1. The T1 tumor here intertwines with the wispy fibers of the muscularis propria but by definition does not invade the smooth muscle fibers of the detrusor. T2 tumors invade the detrusor muscle, and T3 tumors are in extravesical fat as shown.
The presence of bladder cancer is usually suspected by hematuria. Patients with macroscopic (gross) hematuria have reported rates of bladder cancer of 13% to 34.5% (Lee and Davis, 1953; Varkarakis et al, 1974). Microscopic hematuria is associated with a 0.5% to 10.5% rate of bladder cancer (Golin and Howard, 1980; Mohr et al, 1986; Sultana et al, 1996; Khadra et al, 2000). The presence of irritative voiding symptoms may double the risk, especially for CIS (5% vs. 10.5%) (Mohr et al, 1986). The Mayo Clinic reported that 80% of patients with CIS presented with irritative symptoms (Zincke et al, 1985). In a review of 600 patients diagnosed with interstitial cystitis, 1% of the patients had a missed diagnosis of urothelial carcinoma. Of note, two thirds of these patients did not have hematuria (Tissot et al, 2004). Thus cystoscopy and upper tract imaging are indicated in patients with hematuria and/or unexplained irritative symptoms (Grossfeld et al, 2001).
Recurrence is common in all patients with non–muscle-invasive urothelial cancer but can often be controlled successfully with transurethral surgery, intravesical therapy, or a combination. In contrast to recurrence, patients can be divided into low or high risk for progression, which is the true concern. Low-grade Ta lesions are low risk, whereas all high-grade lesions (including CIS) have a high risk of progressing. The frequency of progression and death is shown in Table 81–1.
Table 81–1 Estimates of Disease Progression in Non–Muscle-Invasive Bladder Cancer: World Health Organization/International Society of Urologic Pathology Consensus Classification

Staging
Pathology: Staging and Grading
Although the World Health Organization (WHO) has determined that the term urothelial cancer (UC) is preferable to the term transitional cell cancer (TCC), the latter remains in widespread use. However, their recommendation to move away from the traditional grading system (1 to 3, from low grade to high grade) is now accepted by many urologists and pathologists. They recommend that malignant tumors be classified as low grade or high grade, regardless of invasion status.
In contrast, essentially benign papillary tumors with orderly cellular arrangement, minimal architectural abnormalities, and minimal nuclear atypia are distinct from those two grades and are designated Papillary Urothelial Neoplasm of Low Malignant Potential (PUNLMP). Such tumors would have been labeled either papillomas or grade 1 TCC in older systems but are now regarded as so unlikely to progress that they are considered benign. However, on the basis of this low risk, the WHO recommends that such pathology reports contain the note, “Patients with these tumors are at risk of developing new bladder tumors (“recurrence”), usually of similar histology. However, occasionally these subsequent lesions manifest as UC, such that follow-up of the patient is warranted” (Epstein et al, 1998). Papillomas are truly benign and not associated with risk of progression (Figs. 81-1 through 81-5).

Figure 81–2 The urothelium is thickened, but cells and nuclei are normal in papillary urothelial neoplasm of low malignant potential (×40).

Figure 81–3 Ta low-grade tumor (×40). Cells are relatively normal but exhibit irregularity and some nuclear differentiation.
Pathologic Staging
The bladder has three main histologic layers: (1) urothelium, (2) suburothelial loose connective tissue called lamina propria, and (3) detrusor or muscularis propria (which is absent beneath the urothelium of diverticulae). Stage Ta denotes a papillary tumor confined to the urothelium. CIS (also termed Tis) is a flat, high-grade lesion confined to the same layer, and T1 is a tumor invading lamina propria. The TNM grading system for non–muscle-invasive tumors is demonstrated in Figure 81–1.
The demarcation between “superficial” and “invasive” has sometimes been errantly considered between T1 and T2. However, T1 tumors invade the lamina propria by definition, so they cannot be accurately characterized as “noninvasive.” Unlike the urothelium, which is devoid of vessels or lymphatics, the lamina propria is rich in both, providing opportunity for metastasis. These tumors sometimes invade the wispy and discontinuous muscularis mucosae of the lamina propria, which can be confused for muscularis propria (detrusor) during pathologic interpretation. Imprecise verbiage on the pathology report can lead the urologist to misinterpret invasion of muscularis mucosae to be “muscle invasive,” risking overstaging error. Direct communication between urologist and pathologist when this occurs is essential.
Deep lamina propria invasion carries a substantially more serious prognosis in some reports, and some have proposed these be subcategorized as T1b (Younes et al, 1990). However, the value of substaging has not been validated in other studies, so the 1998 Bladder Cancer Consensus Conference Committee rejected the concept (Platz et al, 1996; Epstein et al, 1998).
Tumor Biology
Low-grade tumors rarely invade the lamina propria or detrusor, so invasive tumors may be almost equated with high-grade histology. However, tumors of all grades and degrees of potential aggressiveness can be identified before invasion of the muscularis propria, so no such grading assumption can be made about these lesions.
Low-grade Ta lesions recur at a rate of 50% to 70% and progress in approximately 5% of cases. In contrast, high-grade T1 lesions recur in more than 80% of cases and progress in 50% of patients within 3 years. This behavior is primarily grade, rather than stage, dependent, because patients with high-grade tumors progressed with similar frequency regardless of whether they were invasive (T1) or noninvasive (Ta) (Herr, 2000a). Prognosis also correlates with tumor size, multiplicity, papillary versus sessile configuration, presence or absence of lymphovascular invasion, and status of the remaining urothelium (Althausen et al, 1976; Lutzeyer et al, 1982; Heney et al, 1983a, 1983b; Kunju et al, 2008).
The variance in biologic behavior for low-grade versus high-grade lesions correlates with the known dual molecular lines of genetic development for these two pathways and supports the concept that high-grade and low-grade cancers may be considered as essentially different diseases (Hasui et al, 1994; Droller, 2005). Chromosomal alterations caused by oxidative DNA damage create two separate genetic pathways to the development of UC (Spruck et al, 1994; Richter et al, 1997; Cote and Chatterjee, 1999). The first and more common (low grade) leads to noninvasive, papillary tumors. These usually follow an indolent course unless they convert to or are associated with a tumor of the second pathway (Kiemeney et al, 1993).
The second pathway leads to the development of high-grade cancer including CIS, T1, and, ultimately, muscle-invasive carcinoma. Such genetic alterations can be evaluated using karyotyping, microsatellite analysis for allelic imbalance (Mao et al, 1996), comparative genomic hybridization (Kallioniemi et al, 1995), DNA ploidy analysis by flow cytometry (Bittard et al, 1996), and fluorescence in-situ hybridization (FISH) (Degtyar et al, 2004). These evaluations can show that low-grade papillary tumors tend to exhibit relatively few chromosomal abnormalities, primarily involving loss of all or part of chromosome 9 (particularly the q arm). In contrast, high-grade tumors tend to have numerous and greatly variable chromosomal gains and losses. In addition to their relatively predictable aneuploidy, high-grade tumors can also lose all or part of chromosome 9 (Richter et al, 1997). Although almost any chromosome can be affected, aneuploidy of chromosomes 7, 9, and 17 is associated with especially aggressive tumors (Olumi et al, 1990; Waldman et al, 1991; Degtyar et al, 2004).
Because of these differing genetic imprints, it has been suggested that papillary pTa tumors could almost be considered benign and might be a completely separate disease entity in contrast to high-grade tumors (Sauter and Mihatsch, 1998; Harnden, 2007). Nevertheless, high-grade and low-grade lesions are known to coexist. UC is traditionally considered a field change disease, with tumors arising at different times and sites. Rarely, patients who initially have low-grade tumors will subsequently develop high-grade tumors, often years after the original tumors, so long-term surveillance is usually reasonable (Prout and Barton, 1992).
Pathologic Characteristics by Stage and Implications for Clinical Staging Errors
Stage Ta tumors are usually low grade. Although recurrence is common, especially in the setting of multiplicity, progression is rare. However, 2.9% to 18% of Ta tumors are high grade, with an average of 6.9% (Sylvester et al, 2005). The most important risk factor for progression is grade, not stage (Norming et al, 1992; Millan-Rodriguez et al, 2000). Stein and colleagues (2001) found little difference in survival comparing noninvasive and muscle-invasive tumors as long as the cancer was organ confined (Stein et al, 2001; Sylvester et al, 2005).
CIS is occasionally mischaracterized as “premalignant” (Sylvester et al, 2005), but it is actually a flat, noninvasive UC that is high grade by definition. Although confined to the urothelium in the same manner as stage Ta, CIS is regarded as a precursor for the development of invasive high-grade cancer.
CIS lesions are composed of severely dysplastic urothelium. Microscopically, the slide will demonstrate disorderly histology with nuclear atypia characteristic of high-grade malignancy; denudement of some or all of the mucosa due to loss of cellular cohesion sometimes complicates interpretation. A pathology report read as dysplasia or atypia can create confusion. Most pathologists consider mild examples of these entities to be benign. However, lesions interpreted as severe dysplasia or severe atypia are regarded as being the same entity as CIS (Epstein et al, 1998). Again, unambiguous communication between pathologist and urologist can minimize the risk for misinterpretation.
Between 40% and 83% of patients with CIS will develop muscle invasion if untreated, especially if associated with papillary tumors (Althausen et al, 1976). Among patients thought to have CIS alone, up to 20% who are treated with cystectomy are found to contain invasion on final pathology (Farrow et al, 1976). The presence of CIS in cystectomy specimens performed for presumed T1 tumors was associated with upstaging in 55% of patients in a recent series, compared with 6% upstaging in patients without CIS (Masood et al, 2004). In a series of 1500 patients, CIS was the second most important prognostic factor after grade (Millan-Rodriguez et al, 2000). Multicentricity presents another ominous characteristic of CIS (Koch and Smith, 1996). The presence of irritative voiding symptoms has been associated with diffuse disease, invasion, and a compromised prognosis, but there is no consensus on this finding in the literature (Smith et al, 1999; Sylvester et al, 2005).
T1 tumors are usually papillary; a nodular or sessile appearance suggests deeper invasion. Deep penetration into the lamina propria, especially if involving muscularis mucosae, increases the risk of recurrence and progression in some reports. Lymphovascular invasion increases the risk as well (Lotan et al, 2005). Hydronephrosis usually indicates muscle invasion.
There is significant potential for understaging in patients with high-grade, apparently non–muscle-invasive tumors, especially for those that appear to be stage T1. Many tumors are found to be more extensive than the transurethral resection (TUR) specimen indicated when patients undergo cystectomy. Stein (Freeman et al, 1995) reported that one third of patients believed to have non–muscle-invasive disease at the time of cystectomy were found to actually have muscle invasion, only half of which were organ confined. Metastases were already present in 8% of these patients (Freeman et al, 1995). Stein’s subsequent review noted that understaging errors from 34% to 62% have been reported (Stein, 2001), and a study from the Mayo Clinic before widespread use of intravesical therapy showed that 78% of patients with clinical T1 disease that underwent cystectomy had muscle invasion, with 62% having extravesical disease. Studies from the past decade addressing the risk of understaging of T1 tumors are shown in Table 81–2.
Table 81–2 Risk of Understaging When Cystectomy Is Performed for Presumed Non–Muscle-Invasive Disease
| STUDY | INSTITUTION | RISK (%) OF UNDERSTAGING |
|---|---|---|
| Stein et al, 2001 | Southern California | 39 |
| Dutta et al, 2001 | Vanderbilt University | 40 |
| Bianco et al, 2004 | Wayne State University | 27 |
| Bayraktar et al, 2004 | Vakif Gureba Hospital | 50 |
| Aksaray-Istanbul, Turkey | ||
| Huguet et al, 2005 | Servicio de Urologia, | 27 |
| Fundacion Puigvert, Barcelona | ||
| Ficarra et al, 2005 | University of Verona, Italy | 43 |
Although it is likely that the patients who underwent cystectomy had more serious risk factors than those who did not, these data offer compelling evidence that the term superficial to describe all such lesions is misleading.
Endoscopic Surgical Management
When bladder cancer is identified during office-based cystoscopy, the location, number, and nature of tumors are recorded, as is involvement of areas likely to reflect extravesical extension such as the ureteral orifices and bladder neck/prostatic urethra. Urinary cytology is obtained as a baseline and to establish the likelihood of high-grade disease. Positivity will encourage random bladder biopsy at the time of TUR as discussed later.
Upper tract imaging is usually performed both to identify other sources of hematuria and to assess the extravesical urothelium due to the “field change” nature of UC that can affect such cells throughout the urinary tract. Expert consensus is that patients with solitary or limited low-grade Ta lesions do not need imaging, owing to the very low risk of extravesical disease (Goessl et al, 1997).
TUR of bladder tumor (TURBT) under regional or general anesthesia is the initial treatment for visible lesions and is performed to (1) remove all visible tumors and (2) provide specimens for pathologic examination to determine stage and grade. Bimanual examination of the bladder should be performed under anesthesia before prepping and draping unless the tumor is clearly small and noninvasive, and it should be repeated after resection. Fixation or persistence of a palpable mass after resection suggests locally advanced disease. An increase in abdominal girth or fullness after resection indicates intraperitoneal perforation.
Complete visualization to plan the resection is facilitated by either the flexible cystoscope or preferably the 70-degree rod lens, which allows maintenance of the anatomic relationships. Resection is performed using a 30-degree lens placed through a resectoscope sheath because this deflection allows visualization of the loop placed at this location. Continuous irrigation with the bladder filled only enough to visualize its contents minimizes bladder wall movement and lessens thinning of the detrusor through overdistention (Koch and Smith, 1996). Video TUR allows magnification, facilitates resident teaching, allows documentation of findings, and reduces the risk of body fluid exposure to the surgeon (Manoharan and Soloway, 2005; Nieder et al, 2005). Resection is performed piecemeal, delaying transection of any stalk until most tumor is resected in order to maintain countertraction. Friable, low-grade tumors can often be removed without the use of electrical energy because the nonpowered cutting loop will break off most segments. This minimizes the chance of bladder perforation. Higher-grade, more solid tumors and the base of all tumors require the use of cutting current; cautery yields hemostasis once all of the tumor is resected. Lifting the tumor edge away from detrusor lessens the chance of perforation (Holzbeierlein and Smith, 2000). Repeated slow fulguration may complicate the ability of the pathologist to determine grade or invasion status.
After all visible tumor is resected, an additional pass of the cutting loop or a cold cup biopsy can be obtained to send to pathology separately to determine the presence of muscle invasion of the tumor base. A chip evacuator gathers the specimen. Final confirmation of hemostasis in the presence of minimal irrigation after all chips are removed through vigorous irrigation is helpful.
Traditionally, TUR has been performed in sterile water because saline solutions conduct electricity and disperse energy from the monopolar cautery cutting loop. Glycine is more expensive, and there is no evidence of its benefit compared with water (Holzbeierlein and Smith, 2000). Introduction of bipolar electroresection is reported to allow transurethral resection in saline (TURIS) and to minimize the risk of the obturator reflex that can predispose to bladder perforation (Shiozawa et al, 2002; Miki et al, 2003). The use of general anesthesia with muscle-paralyzing agents also prevents obturator reflex. This can also be accomplished by direct injection of 20 to 30 mL of local anesthetic (lidocaine) into the obturator nerve and its canal, but few centers have experience with this.
Resection of diverticular tumors presents significant risk of bladder wall perforation, and accurate staging is difficult to achieve in this circumstance because the underlying detrusor is absent. Invasion beyond the lamina propria immediately involves perivesical fat or stage T3a. Resection in diverticula almost inevitably leads to perforation. Low-grade diverticular tumors are best treated with a combination of resection and fulguration of the base. Conservative resection can be followed with subsequent repeat resection if the final pathologic interpretation is high grade. High-grade tumors require adequate sampling of the tumor base, often including perivesical fat, despite the near-certainty of bladder perforation. An indwelling catheter allows healing. Partial or radical cystectomy should be strongly considered for high-grade diverticular lesions.
Anterior wall tumors and tumors at the dome in patients with large bladders can be difficult to reach. Minimal bladder filling combined with manual compression of the lower abdominal wall to bring the tumor toward the resectoscope facilitates removal. Modern resectoscopes are long enough to reach the entirety of most bladders; creation of a temporary perineal urethrostomy offers deeper access but is rarely necessary except in the obese patient with an inaccessible tumor. Digital manipulation through the rectum or vagina can occasionally facilitate resection.
Care must be taken during resection near the ureteral orifice to prevent obstruction from scarring after fulguration. Pure cutting current causes minimal scarring and may be safely performed including resection of the orifice if necessary. Resection of the intramural ureter can lead to complete eradication of the tumor but risks reflux of malignant cells. The clinical implications of this are unclear (Palou et al, 1992).
Alternatively, small tumors may be resected using the cold cup biopsy forceps alone. This is especially helpful in the thin-walled bladder of elderly women, who are predisposed to perforation due to their thin-walled bladder. If perforation occurs, the cup causes a smaller hole than does the cutting loop. A Bugbee electrode facilitates hemostasis. A successful cauterization method involves placing the Bugbee electrode inside the biopsy site with the bladder under minimal distention. Touching the cut surface of the biopsy crater, the electrical energy will cause the mucosa to contract around the electrode unless the bladder is full. Light irrigation clears the area of blood and vaporization bubbles created during fulguration. Visualizing a small (1 to 2 mm) ring of white coagulation confirms hemostasis and yields less damage to the bladder than that occurring when the biopsy area is “painted” with cautery. Removing the electrode from the site before discontinuing the energy current lessens the chance of pulling the fresh clot off as the Bugbee electrode separates from the urothelium.
If a tumor appears to be muscle invasive, biopsies of the borders and base in order to establish invasion may be performed in lieu of complete resection, because cystectomy will likely follow based on confirmatory biopsies. Failure to demonstrate invasion necessitates repeat resection unless the decision is made to proceed to cystectomy-based factors other than muscle invasion.
Complications of Transurethral Resection of Bladder Tumor
Minor bleeding and irritative symptoms are common side effects in the immediate postoperative period. The major complications of uncontrolled hematuria and clinical bladder perforation occur in less than 5% of cases, although a majority of patients will exhibit contrast agent extravasation indicative of minor perforation if cystography is performed. The incidence of perforation can be reduced by attention to technical details, avoiding overdistention of the bladder, and using anesthetic paralysis during the resection of significant lateral wall lesions to lessen an obturator reflex response. Moreover, large, bulky tumors and those that appear to be muscle invasive are often best resected in a staged manner because it is believed that repeat resection can more safely remove residual tumor if indicated.
The vast majority of perforations are extraperitoneal, but intraperitoneal rupture is possible when resecting tumors at the dome (Collado et al, 2000). The risk of tumor seeding due to perforation appears to be low (Balbay et al, 2005). Anecdotal reports have identified extravesical recurrences after perforation, theoretically due to seeding (Mydlo et al, 1999). It has been suggested that the risk of tumor seeding is higher in patients who undergo surgical repair, but this may be related to patient selection because only serious intraperitoneal perforations are likely to be managed in this manner (Mydlo et al, 1999; Skolarikos et al, 2005).
Management of extraperitoneal perforation is usually possible by prolonged urethral catheter drainage. Intraperitoneal perforation is less likely to close spontaneously and often requires open or laparoscopic surgical repair. Decisions for surgical correction should be made on the basis of the extent of the perforation and the clinical status of the patient.
TUR syndrome from fluid absorption is uncommon and managed in the same manner as during TURP. As long as resection of the ureteral orifice is done with pure cutting current, scarring is minimal and obstruction unlikely. Cystoscopy to visualize efflux, which is occasionally aided by intravenous administration of indigo carmine or methylene blue or retrograde ureteropyelography, can determine presence or absence of obstruction. Balloon dilation of the orifice or endoscopic incision can relieve obstruction, but failure to respond may require reimplantation (Chang et al, 1989).
Repeat Transurethral Resection of Bladder Tumor
Complete tumor removal is not always possible, whether due to excessive tumor volume, anatomic inaccessibility, medical instability requiring premature cessation, or risk of perforation. However, even in the absence of these circumstances repeat TUR is often indicated. When repeat TUR is performed within several days to several weeks of the original resection, residual tumor is identified at the site of the initial resection at least 40% of the time (Klan et al, 1991; Mersdorf et al, 1998; Vogeli et al, 1998). In a review, Miladi and coworkers (2003) found that a second TURBT performed within 6 weeks of the initial resection detected residual tumor in 26% to 83% of cases and corrected clinical staging errors in half of those cases. The potential for understaging high-risk disease ranged from 18% to 37% (Amling et al, 1994).
Repeat TURBT is usually appropriate in the evaluation of T1 tumors because a repeat TUR can demonstrate worse prognostic findings in up to 25% of specimens (Schwaibold et al, 2000). This is especially likely if no muscle is identified on initial pathology, which can occur in almost half of cases. The Vanderbilt University group reported a 64% risk of understaging T1 lesions when muscle was absent, compared with 30% when muscle was present in the specimen (Dutta et al, 2001). Herr (1999) reported that a second resection changed treatment in one third of cases. Importantly, survival was 63% in patients who underwent a second TURBT versus 40% for those who did not in a German observational study (Grimm et al, 2003). The efficacy of bacillus Calmette-Guérin (BCG) in preventing progression appears to be higher in patients with high-grade papillary tumors and CIS if a restaging TURBT was performed before instillation of BCG (Herr, 2005).
There appears to be variability in completeness of resection among surgeons. In patients with multiple tumors who had adjuvant treatment, recurrence rates varied between 7.4% and 45.8% depending on the surgeon (Brausi et al, 2002). Repeat resection is helpful in the setting of a second opinion unless clear evidence of muscle invasion is identified on the initial resection, especially if the outside pathology slides are not available for review.
Consensus is that patients with pT1 and high-grade Ta tumors merit repeat resection. There is no consensus on timing of repeat TURBT, but most authors recommend 1 to 6 weeks after the initial resection (Nieder et al, 2005).
Role of “Random” or Additional Biopsies
Biopsies of any suspicious areas are an important part of a complete evaluation. Cold-cup biopsies may not provide as much information regarding muscular invasion but provide tissue sampling without cautery artifact that can interfere with pathologic interpretation (Soloway et al, 1978; Smith, 1986a, 1986b).
On the basis of the understanding that CIS can exist in normal-appearing urothelium, some authors advocate the use of random biopsies to identify CIS in otherwise normal-appearing mucosa. This remains controversial. May and colleagues (2003) performed random biopsies in high-risk patients and found that the results were positive in 12.4% and altered treatment in 7% including 14 of 1033 patients in whom the only positive tissue was in the random biopsy, not the primary resected tumor. However, even when velvety red patches were sampled, only 11.9% of biopsies were positive in one report (Swinn et al, 2004). A European Organisation for Research and Treatment of Cancer (EORTC) retrospective review found that 10% of random biopsies were positive (3.5% CIS) and concluded such biopsies were not warranted (van der Meijden et al, 1999). Fujimoto and colleagues (2003) prospectively evaluated the role of random biopsies of normal-appearing urothelium and found cancer in only 8 of 100 biopsy samples, 5 of which were CIS. They concluded that random biopsies are indicated only in the setting of multiple tumors or positive cytology. The current consensus is that random biopsies are not indicated in low-risk patients (i.e., those with low-grade papillary tumors and negative cytology).
Prostatic urethral biopsy using the cutting loop may be performed, especially if neobladder creation is anticipated for high-risk disease, but bleeding may be more common (Holzbeierlein and Smith, 2000). The additional value of the information obtained from cold cup and urethral biopsies must be weighed against the theoretical risk that biopsies provide an exposed bed to aid tumor implantation (Mufti and Singh, 1992; Kiemeney et al, 1994; Yamada et al, 1996). Traditional teaching is that TUR of the prostate (TURP) and TURBT of a low-grade bladder tumor may be performed at the same setting but that resection of a high-grade bladder tumor should not be resected coincident to TURP to avoid tumor seeding and possible intravasation of tumor cells likely to metastasize. Despite anecdotal reports of low-grade tumors implanting in the prostatic urethra after simultaneous resection, this risk appears to be small and the literature does not adequately address the risk of metastasis in this setting (Tsivian et al, 2003).
Perioperative Intravesical Therapy to Prevent Tumor Implantation
It is believed that tumor cell implantation immediately after resection is responsible for many early recurrences and this has been used to explain the observation that initial tumors are most commonly found on the floor and lower side walls of the bladder, whereas recurrences are often located near the dome (Heney et al, 1981). Thus intravesical chemotherapy to kill such cells before implantation has been used (Zincke et al, 1983; Klan et al, 1991).
Mitomycin C (MMC) appears to be the most effective adjuvant intravesical chemotherapeutic agent perioperatively, although epirubicin is used in Europe and direct comparative studies are lacking (Witjes and Hendricksen, 2008). Consistent with its proposed mechanism of action to prevent tumor cell implantation, a single dose administered within 6 hours lessens recurrence rates, whereas a dose 24 hours later does not (Isaka et al, 1992; Oosterlinck et al, 1993; Sekine et al, 1994; Solsona et al, 1999; Duque and Loughlin, 2000), and maintenance therapy does not reduce the risk further (Bouffioux et al, 1995; Tolley et al, 1996). Nevertheless, the level 1 data in support of single-dose MMC immediately after resection to reduce tumor recurrence are compelling (Table 81–3).
Table 81–3 Successful Perioperative Administration of Intravesical Chemotherapy
Modified from O’Donnell MA. Practical applications of intravesical chemotherapy and immunotherapy in high-risk patients with superficial bladder cancer. Urol Clin North Am 2005;32:121–31.
A meta-analysis found that low-risk patients at a median follow-up of 3.4 years experience an approximate 39% drop in the odds of recurrence (i.e., from 48.4% to 36.7%). Patients with multiple tumors experience a 56% reduction in the odds of recurrence. MMC, epirubicin, and pirarubicin all significantly lessened the recurrence of both single and multiple tumors. Thiotepa did not show the same benefit, but data were limited and some studies used dilute strengths (Sylvester et al, 2004). The number needed to treat (NNT) to prevent one recurrence in the meta-analysis was 8.5, so some authors suggest that intravesical chemotherapy reduces overall cost of care by reducing the need for secondary resections. However, subsequent studies have shown that the tumors prevented are primarily smaller tumors that are often treated in the office or ambulatory surgery setting (Berrum-Svennung et al, 2008). In addition, the benefit appears limited to patients with low risk of recurrence (Gudjónsson et al, 2009), so the economic benefit regarding recurrences appears limited if treated in any manner other than inpatient care (Rao and Jones, 2009).
Although local irritative symptoms are the most common complications of postoperative instillation, serious sequelae and rare deaths have occurred, especially in patients with perforation during resection (Oddens et al, 2004). Chemotherapy should be withheld in patients with extensive resection or when there is concern about perforation.
BCG can never be safely administered immediately after TUR because the risk of bacterial sepsis and death is high.
Laser Therapy
Laser coagulation allows minimally invasive ablation of tumors up to 2.5 cm in size. The neodymium : yttrium-aluminum-garnet (Nd : YAG) laser has the best properties for use in bladder cancer. Lesions can be coagulated until nonviable through protein denaturation using a straight or 90-degree noncontact “free beam” laser using power output of up to 60 W. The most significant complication of laser therapy is forward scatter of laser energy to adjacent structures, resulting in perforation of a hollow, viscous organ such as overlying bowel. This is rare but most commonly occurs with the neodymium : YAG laser because of its deeper tissue penetration than with holmium : YAG and KTP lasers (Smith, 1986a, 1986b). Unless higher energy is necessary for a very large tumor, limiting energy to 35 W precludes exceeding 60° C on the outer bladder wall, minimizing the risk of perforation (Hofstetter et al, 1994). The most efficient delivery appears to be an end-fire noncontact fiber with a 5- to 15-degree angle of divergence, which allows variable penetration depth up to 5 mm (Smith and Landau, 1989; Holzbeierlein and Smith, 2000). Treatment should be under direct visualization and should discontinue as soon as protein denaturation is evident by the white appearance of the treated tissue. Persistence after this occurs risks extravesical injury.
Laser therapy can be more expensive than resection due to the cost of laser fibers, but bleeding is negligible and there is no risk of obturator reflex. Small lesions can be treated easily using intravesical anesthesia. Because there is no tissue available for pathologic inspection, the optimal candidate for laser therapy is the patient with recurrent, low-grade lesions whose biology is already known. Additional information regarding tumor grade may be obtained with a cold cup biopsy if necessary. Some reports suggest lower recurrence rates using laser compared with TURBT, but this remains inconclusive (Smith et al, 1983; Malloy et al, 1984; Beisland and Seland, 1986; Smith, 1986a, 1986b; Beer et al, 1989).
Holmium : yttrium-aluminum-garnet (YAG), argon, and potassium titanyl phosphate (KTP) lasers ablate tissues by cutting (vaporization) and thus have limited applicability due to lack of deep coagulation (Johnson et al, 1991; Benson, 1992; Holzbeierlein and Smith, 2000). The carbon dioxide laser is completely absorbed by fluid, so it is not appropriate for use in the treatment of bladder cancer (Benson, 1992).
Office-Based Endoscopic Management
Many patients with small (<0.5 mL) low-grade recurrences can be managed safely in the office setting using diathermy or laser ablation under intravesical local anesthetic (Donat et al, 2004). Instillation of viscous or injectable 1% to 2% lidocaine through a catheter and a dwelling time of 15 to 30 minutes yield satisfactory mucosal analgesia. Pain with fulguration of 1- to 2-mm tumors is often acceptable with no analgesia. A tissue diagnosis and a negative cytology for the initial tumor occurrence are mandatory to determine whether the tumor is of high or low grade.
Additionally, many small, low-grade tumors can be safely observed until they exhibit significant growth due to the minimal risk of progression (Soloway et al, 2003: Pruthi et al, 2008). These conservative approaches can obviate the need for anesthesia and use of hospital-based resources for selected small, low-grade recurrences.
Fluorescence Cystoscopy
Endoscopically, urologists can suspect malignancy only on the basis of the presence of visible changes such as tumors or “red spots.” As noted, random biopsy of normal-appearing areas sometimes detects unsuspected malignancy, usually CIS. Moreover, a multicenter study found that 37% of the biopsies performed on the basis of suspicious endoscopic findings resulted in false-negative biopsy, emphasizing the subjectivity and attendant false-positive and false-negative rates of cystoscopy (Riedl et al, 2001; Sarosdy et al, 2002). The imperfect sensitivity of cystoscopy potentially explains the high rate of cancer recurrence soon after complete removal of all visible tumors (tumor cell implantation also contributing, as described earlier). It is likely that cancer was already present but not visible at the time of resection and simply became visible in follow-up when it became morphologically abnormal enough to differentiate from adjacent normal urothelium.
Photoactive porphyrins accumulate preferentially in neoplastic tissue. Under blue light they emit red fluorescence, which can help in the diagnosis of indiscernible malignant lesions. Hematoporphyrin derivatives must be administered systemically and can cause lengthy, residual cutaneous photosensitization. Intravesical application of 5-aminolevulinic acid (5-ALA), a precursor of photoactive porphyrin, avoids residual systemic photosensitization and has improved the detection of bladder tumors. Modifications of 5-ALA may allow deeper tissue penetration and improved accumulation in neoplastic cells (Lange et al, 1999). A more lipophilic ester, hexaminolevulinate (HAL), is the most studied agent.
When using this technology, both small papillary tumors and almost one-third more cases of CIS overlooked by cystoscopy are identified (Jichlinski et al, 2003; Schmidbauer et al, 2004; Fradet et al, 2007). Of all tumors, 96% were detected with HAL imaging compared with 77% using standard cystoscopy. Detection was improved for dysplasia (93% vs. 48%), CIS (95% vs. 68%), and papillary tumors (96% vs. 85%) (Jocham et al, 2005). The clinical impact of improved tumor detection seems intuitive, and prospective evidence shows that this decreases recurrence rates in patients who undergo HAL fluorescence cystoscopy compared with controls (Filbeck et al, 2003; Denzinger et al, 2007).
Intravesical HAL for use with fluorescence cystoscopy received approval for use in Europe in 2004. A multinational study to determine the actual impact on recurrence rates before approval in North America showed similar findings (unpublished data) (Figs. 81-6 and 81-7).

Figure 81–6 White light microscopy reveals normal appearing mucosa.
(Courtesy of H. Barton Grossman, MD.)

Figure 81–7 Blue light microscopy reveals accumulation of hexaminolevulinate in an area proven subsequently to contain a small focus of carcinoma in situ.
(Courtesy of H. Barton Grossman, MD.)
Key Points: Endoscopic Surgical Management
Immunotherapy
Intravesical immunotherapy results in a massive local immune response characterized by induced expression of cytokines in the urine and bladder wall and by an influx of granulocytes, mononuclear, and dendritic cells (Shen et al, 2008). The mechanism of action has been intensively investigated. The initial step appears to be direct binding to fibronectin within the bladder wall, subsequently leading to direct stimulation of cell-based immunologic response and an antiangiogenic state. Numerous cytokines involved in the initiation or maintenance of inflammatory processes including tumor necrosis factor (TNF)-α, granulocyte-macrophage colony-stimulating factor (GM-CSF), interferon (IFN)-γ, and interleukin (IL)-1, IL-2, IL-5, IL-6, IL-8, IL-10, IL-12, and IL-18 have been detected in the urine of patients treated with intravesical BCG and other immunostimulatory agents. The observed pattern of cytokine induction with preferential upregulation of interferon-γ, IL-2, and IL-12 reflects induction of a T-helper type-1 (Th1) response. This immunologic response activates cell-mediated cytotoxic mechanisms that are believed to underlie the efficacy of BCG and other agents in the prevention of recurrence and progression (Bohle and Brandau, 2003). In addition, BCG may concomitantly stimulate IL-10, resulting in the suppressive T-helper type-2 (Th2) response. Increasing the predominance of the Th1 response versus the Th2 response is an area of continued research (Lou, 2003). Overall, response to intravesical immunotherapy may be limited if a patient has an immunosuppressive disease or by advanced age (Joudi, 2006a, 2006b).
Bacillus Calmette-Guérin
BCG is an attenuated mycobacterium developed as a vaccine for tuberculosis that has demonstrated antitumor activity in several different cancers including UC (Morales et al, 1976). The original regimen described by Morales included a percutaneous dose, which was discontinued after success using a similar intravesical regimen by Brosman (1982).
BCG is stored in refrigeration and reconstituted from a lyophilized powder. Connaught, Tice, Armand Frappier, Pasteur, Tokyo, and RIVM strains all arise from a common original strain developed at the Pasteur Institute. The vaccine is reconstituted with 50 mL of saline and should be administered through a urethral catheter under gravity drainage soon thereafter to avoid aggregation (Ratliff et al, 1994). Treatments are generally begun 2 to 4 weeks after tumor resection, allowing time for re-epithelialization, which minimizes the potential for intravasation of live bacteria (Lamm et al, 1992b). For the same reason, a urinalysis is usually performed immediately before instillation to further ensure a diminished probability of systemic uptake of BCG. In the event of a traumatic catheterization, the treatment should be delayed for several days to 1 week, depending on the extent of injury. After instillation, the patient should retain the solution for at least 2 hours. Some clinicians have advocated the patient turn from side to side to bathe the entire urothelium, but there is no scientific support for this practice. Fluid, diuretic, and caffeine restriction before instillation is essential to limit dilution of the agent with urine and to facilitate retention of the agent for 2 hours (Lamm et al, 2000a). Patients are instructed to clean the toilet with bleach, although there is no demonstrable risk of close contact infection.
BCG Treatment of Carcinoma in Situ
American urologists use BCG by a 2 : 1 margin compared with intravesical adjuvant or maintenance chemotherapy (e.g., doxorubicin hydrochloride [Adriamycin], gemcitabine, thiotepa), whereas European urologists favor chemotherapy. BCG is approved for this indication by the U.S. Food and Drug Administration (FDA). Before the adoption of BCG intravesical therapy, CIS reportedly progressed at an average rate of 7% per year (Zinke, 1985).The initial tumor-free response rate is as high as 84% (Brosman, 1982; DeJager et al, 1991; Hudson and Herr, 1995; Lamm et al, 2000a, 2000b, 2000c). Approximately 50% of patients experience a durable response for a median period of 4 years. Over a 10-year period, approximately 30% of patients remain free of tumor progression or recurrence, so close follow-up is mandatory. The majority of these occur within the first 5 years (Herr et al, 1992). Herr and coworkers (1989) reported progression in 19% of initial responders at 5 years but found the rate to be 95% in nonresponders—findings confirmed by other investigators (Coplen et al, 1990; Harland et al, 1992). The American Urological Association (AUA) Guidelines Panel supported BCG as the preferred initial treatment option for CIS (Hall et al, 2007).
BCG has gained a pre-eminent role in North America on the basis of higher efficacy reports compared with intravesical chemotherapy, despite greater morbidity than chemotherapy (O’Donnell, 2007). In more than 600 patients, there was a 68% complete response rate to BCG and a 49% complete response rate to chemotherapy. In responders, 68% of patients treated with BCG remained free of disease as compared with 47% of patients receiving chemotherapy, on the basis of a median follow-up of 3.75 years. The overall disease-free rates were 51% and 27%, respectively (Sylvester et al, 2005).
BCG Treatment of Residual Tumor
Intravesical BCG can effectively treat residual papillary lesions but should not be used as a substitute for surgical resection. Investigators have demonstrated a nearly 60% response by residual tumor with intravesical BCG alone (Brosman, 1982; Schellhammer et al, 1986; Coplen et al, 1990).
Carcinoma of the mucosa or the superficial ducts of the prostate can be adequately treated by BCG with a 50% tumor-free rate. A limited TURP can be effective in decreasing tumor burden and facilitating exposure of the prostate surface to BCG administration (Bretton et al, 1990; Schellhammer et al, 1995).
BCG Prophylaxis to Prevent Recurrence
Early single-center studies demonstrated an advantage in decreased tumor recurrence of approximately 30% when a 6-week course of BCG was administered after recovery from TURBT (Brosman, 1982; Morales et al, 1992). In several larger series, tumor recurrence after TURBT was reduced by 20% to 65%, for an average of approximately 40% (Pagano et al, 1991a, 1991b; Herr et al, 1992; Melekos et al, 1993; Krege et al, 1996). Han and Pan published a meta-analysis in 2006 evaluating 2000 patients with Ta, T1, and/or CIS disease. Patients receiving maintenance BCG had a statistically decreased rate of recurrence compared with those receiving induction therapy alone (Han and Pan, 2006).
The efficacy of BCG after TURBT for high-risk papillary disease has been demonstrated in several series of T1 lesions, with recurrence rates of 16% to 40% and progression rates of 4.4% to 40%, a substantial improvement compared with TUR alone (Cookson and Sarosdy, 1992; Pansadoro et al, 1995; Herr, 1997; Jimenez-Cruz et al, 1997; Gohji et al, 1999; Hurle et al, 1999a, 1999b). Tumor multiplicity and associated CIS were associated with increased risk of progression. Substaging lesions on the basis of the presence or absence of muscularis mucosae invasion in a series of 49 patients did not improve prediction of recurrence (69% vs. 65%) or progression (22% vs. 29%) after BCG therapy (Kondylis et al, 2000).
Impact of BCG on Progression
Although reports of the impact of BCG on tumor recurrence are compelling, the greater need is the potential for impact on progression. In 403 patients with CIS, BCG reduced the risk of progression by 35% compared with intravesical chemotherapy (Sylvester, 2002).
In a randomized trial of 86 patients with high-risk superficial disease, Herr and colleagues (1988) demonstrated a greater delay in interval progression for BCG patients versus TUR controls. Additionally, the cystectomy rate was significantly decreased for CIS patients treated with BCG (11% vs. 55% for controls), as was the time to cystectomy. However, only 27% of patients were alive with an intact functioning bladder after follow-up over 10 to 15 years, so this apparent advantage is temporary in many cases (Cookson et al, 1997). Available data suggest that BCG can delay progression of high-risk bladder cancer, yet the long-term survival advantage is hypothetical.
Nevertheless, two meta-analyses have concluded that BCG reduces the risk of progression. Progression at 2.5 years’ median follow-up was reduced by 27% (9.8% for BCG vs. 13.8% for non-BCG) in one (Sylvester, 2002) and by 23% (7.7% for BCG vs. 9.4% for MMC) at 26-month median follow-up in another analysis (Bohle and Bock, 2004). In both cases the superior results with BCG were only seen in trials using BCG maintenance therapy. In contrast, no chemotherapy trials have achieved a significant reduction in progression (Grossman et al, 2008).
Nuclear P53 overexpression before BCG therapy has not been shown to predict response to therapy, but post-therapy P53 overexpression is an independent marker of disease progression (Lacome et al, 1996; Lebret et al, 1998). The AUA Guidelines panel concluded that BCG appeared likely to reduce progression (Hall et al, 2007).
Determining Optimum BCG Treatment Schedule
The optimal treatment schedule and dose for BCG have not been established. Morales wrote in the reply to an editorial comment to his landmark article (see box), “This regimen is arbitrary, and may be modified in the future as additional data become available” (Morales et al, 1976). In reality, several studies suggest that a 6-week induction course alone is insufficient to obtain an optimal response in many patients and that maintenance therapy is requisite (Lamm et al, 2000a, 2000b, 2000c; Palou et al, 2001).
One of the enduring urban myths in urology is the story of Dr. Alvaro Morales’ initial work with BCG. Although the rumor is usually stated that he chose the dosing regimen based on the fact the drug is shipped in a “6-pack,” he relates that there is more to the story:
“A contemporary abstract had indicated that BCG was ineffective for bladder cancer. However, from our experience and that of others, we knew that at least a 3-week period of immunizations was needed for mounting a delayed hypersensitivity reaction. The intradermal administration provided not only assurance of an enhanced systemic recognition, but also an inexpensive and readily available marker of immune competence. To this day, I remain convinced that eliminating the simultaneous transdermal administration is very convenient for patients and physicians but is not as effective. It was our impression that the skin reactions reached by weeks 4 to 5 were not further enhanced by more BCG. The Frappier labs provided us with boxes of six vials. We thus—for better or worse—decided to stop treatment at 6 weeks, assuming that what was seen on the skin was occurring on the bladder mucosa. Fortunately, that turned out to be true. Bohle and others reported years later that 6 weeks were ideal for maximum response to BCG, although we now know that maintenance dosing enhances response even further.”
The average additional response to a second induction course is 25% in those patients treated for prophylaxis and 30% in CIS patients (Haaff et al, 1986a, 1986b; Kavoussi et al, 1988; Bretton et al, 1990; Coplen et al, 1990; Sylvester, 2002; Bohle and Bock, 2004). However, additional courses of BCG to treat refractory patients after a second 6-week course are accompanied by a significant risk of tumor progression in 20% to 50% of patients (Nadler et al, 1994). Catalona and colleagues (1987) reported roughly a 7% actuarial risk of progression with every additional course of BCG therapy. Response to BCG at 6 months can be used as a predictor of prognosis, with the number of patients developing progressive disease being significantly higher among nonresponders (Orsola et al, 1998).
The Southwest Oncology Group (SWOG) reported the most significant impact of maintenance therapy. Patients received a 6-week induction course followed by three weekly instillations at 3 and 6 months and every 6 months thereafter for 3 years. Estimated median recurrence-free survival was 76.8 months in the maintenance arm and 35.7 months in the control arm (P = .0001). Average recurrence-free survival was 111.5 months in the control arm and not able to be estimated in the maintenance arm (P = .04). Overall 5-year survival was 78% in the control arm and 83% in the maintenance arm. No toxicities above grade 3 were observed, yet only 16% of patients tolerated the full dose-schedule regimen. Two thirds of the patients who stopped BCG due to side effects did so in the first 6 months, suggesting that the side effects do not increase appreciably with additional time on therapy. An interpretation that the intended full course of maintenance therapy cannot be accomplished in most patients due to side effects is misleading. Due to the fact that the treatment group fared better despite most patients failing to complete the full course of therapy, the maximum benefit may have been achieved earlier. Shorter maintenance schedules and reduced dosages may accomplish the same results with less toxicity (Lamm et al, 2000b).
Although some older studies failed to identify a benefit to maintenance therapy (Badalament et al, 1987), most authorities believe that at least 1 year of maintenance therapy is appropriate. Clearly for high-grade T1 lesions or CIS, maintenance therapy has proven superior in multiple studies (Palou et al, 2001). The determination of whether the optimal treatment schedule should be as described in the SWOG study or monthly remains unclear, and optimal duration of a monthly maintenance schedule, if chosen, is unknown (Lamm et al, 2000a, 2000b, 2000c; O’Donnell, 2005). The authors routinely administer the first of three maintenance doses immediately after the scheduled cystoscopy confirms absence of recurrence, with the two following doses weekly thereafter.
Several investigators have evaluated the potential for BCG dose reduction (Morales et al, 1992; Melekos et al, 1993; Martinez-Pineiro et al, 1995; Pagano et al, 1995). In general, a decrease in toxicity with no statistical difference in efficacy has been noted in small series (Pagano et al, 1991b; Mack and Frick, 1995; Hurle et al, 1996), although multifocal and high-grade tumors may respond better to full dosing (Martinez-Pineiro et al, 2002). Some studies have shown an upregulation of the Th1 response with a lower-dose BCG. Lengthening of the instillation interval may decrease side effects without loss of efficacy (Bassi et al, 2000). European studies, where BCG inoculation for tuberculosis is more common than in North America, suggest the dose may be safely reduced by half (Martinez-Pineiro et al, 2002). The difference in response to doing so in immunologically naive North Americans is unknown, but Morales and colleagues (1992) found a significant decrease in response rates (67% vs. 37%), especially for patients with CIS in combination with papillary tumors treated with the reduced dose.
Antibiotic therapy may have a beneficial effect in treating or preventing systemic side effects of BCG therapy, yet it may also inhibit the effectiveness of BCG therapy if it is given routinely for urinary tract prophylaxis during a course of BCG therapy (Durek et al, 1999a, 1999b). Quinolones in particular may affect the viability of BCG and should be avoided if possible during the course of BCG treatments (Durek et al, 1999b). In contrast, in vitro data suggest that quinolone antibiotic therapy may augment intravesical chemotherapy with agents such as doxorubicin because both agents affect topoisomerase II inhibitors (Kamat et al, 1999) (Tables 81-4 and 81-5).
Table 81–4 Contraindications to Bacillus Calmette-Guérin (BCG) Therapy
| Absolute Contraindications |
| Relative Contraindications |
| No or Insufficient Data on Potential Need for Contraindications |
From Ehlers S. Why does tumor necrosis factor targeted therapy reactivate tuberculosis? J Rheumatol (Suppl.) 2005;74:35–9.
Table 81–5 Cleveland Clinic Approach to Management of Bacillus Calmette-Guérin (BCG) Toxicity
| Grade 1: Moderate Symptoms <48 Hr |
| ASSESSMENT |
| SYMPTOM MANAGEMENT |
| Grade 2: Severe Symptoms and/or >48 Hr |
| ASSESSMENT |
| MANAGEMENT |
| ANTIMICROBIAL AGENTS |
| Grade 3: Serious Complications (Hemodynamic Changes, Persistent High-Grade Fever) |
| ALLERGIC REACTIONS (JOINT PAIN, RASH) |
| SOLID ORGAN INVOLVEMENT (EPIDIDYMITIS, LIVER, LUNG, KIDNEY, OSTEOMYELITIS, PROSTATE) |
From Walton Tomford, MD, Cleveland Clinic.
Interferon
Interferons are glycoproteins produced in response to antigenic stimuli. Interferons have multiple antitumor activities including inhibition of nucleotide synthesis; upregulation of tumor antigens, antiangiogenic properties; and stimulation of cytokine release with enhanced T and B cell activation, as well as enhanced natural killer cell activity (Naitoh et al, 1999). Among several subtypes, interferon-α has been the most extensively studied. It is most active in doses of at least 100 million units, although optimal dose and administration schedule have yet to be determined (Torti et al, 1988; Belldegrun et al, 1998).
Interferon as a solitary agent is more expensive and less effective than BCG or intravesical chemotherapy in eradicating residual disease, preventing recurrence of papillary disease, and treating CIS (20% to 43% complete response). Its long-term efficacy for CIS is less than 15% (Belldegrun et al, 1998). A randomized trial demonstrated CIS responses from 5% at low doses (10 million units) to as high as 43% at high doses (100 million units) (Torti et al, 1988). As a prophylactic agent, interferon alone demonstrated recurrence rates that were generally inferior to those of BCG alone (from 60% to 16%) (Glashan, 1990; Kalble et al, 1994). It has demonstrated limited activity against T1 tumors (Malmstrom, 2001). However, it can occasionally be effective in patients who have failed BCG (15% to 20% complete response, see later).
Interferon-α has also been studied in a combination treatment regimen with either chemotherapy or BCG (Bercovich et al, 1995; Stricker et al, 1996). There appeared to be additive effects with either epirubicin or MMC. Several trials investigated the combination of BCG and interferon and suggested the potential superiority of the combination or the possibility of decreasing the dosage of BCG, which may reduce side effects. Initial pioneering work by O’Donnell and colleagues in 2001 reported a 63% disease-free rate at 12 months and 53% at 24 months using combination therapy. In a larger trial of 1000 overall patients, 231 patients with CIS were evaluated. In those CIS patients who failed an induction course of BCG, the combination of low-dose BCG and interferon produced a 45% durable response at 2 years. However, in those patients who had CIS and were BCG naïve, the BCG/interferon combination treatment resulted in 59% disease-free status at 24 months (Joudi, 2006a). Overall, patients who failed BCG alone within 12 months had a poor response to combination therapy. Of the nonresponders to combination BCG/interferon, the majority of patients who failed with recurrence did so within 4 months of initial treatment (Grossman et al, 2008).
Investigational Immunotherapeutic Agents
A number of novel agents have shown potential, but none has reached clinical practice. Keyhole-limpet hemocyanin (KLH) from the hemolymph of the mollusk Megathura crenulata is a nonspecific immune stimulant whose potential effectiveness in UC was identified serendipitously (Olsson et al, 1974; Jurincic et al, 1989). Bropirimine is an oral arylpyridinone that is an inducer of host interferon and induces natural killer cell and tumor necrosis factor, demonstrating a 23% to 55% complete response in patients with CIS (Sarosdy et al, 1992). Mycobacterial cell wall DNA extract contains a mixture of immunostimulatory DNA attached to antigenic cell wall. Phase 2 trial results indicate success rates less than that achieved with BCG, but with good tolerability (Morales et al, 2001). Thiosulfinate extracts of garlic were demonstrated to inhibit tumor growth in older studies and may have an immunostimulatory role (Riggs et al, 1997; Lamm and Riggs, 2001). Several reports have suggested immunostimulatory activity of mistletoe extract (Elsasser-Biele et al, 2005).
Interleukin-12 (IL-2) is highly expressed after BCG stimulation and is a key component of the Th1 immune response. Preclinical data suggest a potential benefit and little toxicity (Horinaga et al, 2005). Multiple studies have documented the potential use of either intravesical IL-2 alone, with BCG, or with BCG and interferon (Shapiro et al, 2007). Preclinical data identifying the efficacy of liposome-mediated intravesical IL-2 with biologic response modifiers have elucidated long-term T-cell memory against muscle-invasive and non–muscle-invasive bladder cancer (NMIBC) (Horiguchi et al, 2000; Larchian et al, 2000). Recent work at MD Anderson has led to a clinical trial employing adenoviral-delivered GM-CSF for BCG refractory bladder cancer.
Clinical studies evaluating the use of antiangiogenic agents for the treatment of refractory bladder cancer have begun at multiple institutions. The evaluation of these agents in concert with intravesical immunotherapy is now being reported (Patel et al, 2009).
Key Points: Immunotherapy
Intravesical Chemotherapy
Induction therapy using chemotherapeutic agents instilled within 6 hours of TURBT has demonstrated a clear impact on recurrence rates, as described earlier. However, the role of chemotherapy in the adjuvant setting is less clear compared with the efficacy of BCG. A SWOG comparison of doxorubicin and BCG showed a 15% progression rate in BCG patients compared with a 37% progression rate in chemotherapy patients (Lamm et al, 1991). Nevertheless, the risk of BCG infectious complications is nonexistent with chemotherapy, leading many in the European community to favor this approach.
The agents are summarized in Table 81–6.
Mitomycin C
Mitomycin C is an alkylating agent that inhibits DNA synthesis. The drug is usually instilled weekly for 6 to 8 weeks at dose ranges from 20 to 60 mg. A meta-analysis of nine clinical trials compared its efficacy on progression with that of BCG. Within median follow-up of 26 months, 7.67% of the patients in the BCG group and 9.44% of the patients in the MMC group developed tumor progression (Bohle and Bock, 2004). Another review found a 38% reduction in tumor recurrence with MMC. This was not as effective as BCG but was considered in most studies to make MMC a viable option in light of its lesser side effects, particularly the low but real risk of sepsis (Huncharek et al, 2001).
Optimization of MMC delivery can result in halving of the recurrence rate in some studies. This can be achieved by eliminating residual urine volume, overnight fasting, using sodium bicarbonate to reduce drug degradation, and increasing concentration to 40 mg in 20 mL (Au et al, 2001). The use of local microwave therapy in conjunction with MMC, 20 mg/50 mL, reduced recurrence rates from 57.5% to 17.1% in a multicenter trial. A study using microwave with higher doses of 40 to 80 mg for 6 to 8 weeks in high-grade bladder cancer found a recurrence-free rate of 75% at 2 years (Gofrit et al, 2004; van der Heijden et al, 2004).
Electromotive intravesical MMC appears to improve drug delivery into bladder tissue (Di Stasi and Riedl, 2009). This treatment reported reduction in recurrence rates with MMC from 58% to 31%, whereas patients in the BCG control arm had a 64% recurrence rate (Di Stasi et al, 2003). Peak plasma MMC was significantly higher in the electromotive group, supporting its reputed mechanism of action.
Doxorubicin and Its Derivatives
Doxorubicin (Adriamycin) is anthracycline antibiotic that acts by binding DNA base pairs, inhibiting topoisomerase II, and inhibiting protein synthesis. In a review, doxorubicin demonstrated a 13% to 17% improvement over TUR in preventing recurrence but no advantage in preventing tumor progression (15.2% vs. 12.6%) (Kurth et al, 1997). The principal side effect of intravesical doxorubicin is chemical cystitis, which can occur in up to half of patients. Reduced bladder capacity has been reported in several series (Thrasher and Crawford, 1992).
The doxorubicin derivative epirubicin decreases recurrence compared with TUR alone by 12% to 15% (Oosterlinck et al, 1993). This was demonstrated when epirubicin was given in a single, immediate, perioperative dose, as well as in full 8-week courses of intravesical therapy. Epirubicin is available for UC in Europe and FDA approved but is unavailable for treatment of UC in the United States.
Valrubicin is a semisynthetic analog of doxorubicin that was approved by the FDA for treatment of BCG refractory CIS in patients who cannot tolerate cystectomy and became available in 2009 in the United States (Sweatman et al, 1991; Greenberg et al, 1997; Grossman et al, 2008). In a cohort of 90 patients with BCG-refractory CIS, 21% demonstrated a complete response (Steinberg et al, 2000).
Thiotepa
Thiotepa (triethylenethiophosphoramide) is the only chemotherapeutic agent approved by the FDA specifically for the intravesical treatment of papillary bladder cancer. It is an alkylating agent and is not cell cycle specific. In controlled clinical trials (N = 950 patients), it has been shown to significantly decrease tumor recurrence in 6 of 11 studies by up to 41% (mean decrease, 16%). Systemic side effects can be seen owing to its low molecular weight, resulting in up to half of administered doses being absorbed and risking hematopoietic toxicity (Thrasher and Crawford, 1992). Nevertheless, most centers have substituted its use with BCG or the above chemotherapeutic agents.
Novel Agents
Gemcitabine and the taxanes paclitaxel and docetaxel have demonstrated activity against metastatic bladder cancer (Calabro and Sternberg, 2002). Intravesical gemcitabine can be safely administered either weekly or twice weekly for six to eight treatments. Minimal systemic absorption occurs through the bladder. Several small phase 1 and phase 2 studies have demonstrated reduction of recurrence of 39% to 70% including modest efficacy in heavily pretreated BCG-refractory patients (Maymi et al, 2004; O’Donnell, 2005). Taxanes have been formulated into an active intravesical treatment, but current published data are limited to preclinical studies (Le Visage et al, 2004).
Combination Therapy
Combining mechanisms of different agents is a logical and often successful approach to improve response rates for systemic therapy. However, studies have not identified clear benefit to doing so in intravesical therapy. For instance, in the study by Fukui and coworkers (1992), MMC (20 mg) was administered on day 1 and doxorubicin (40 mg) on day 2 once a week for 5 weeks in 101 patients. Fifty-one patients demonstrated a complete response and were further randomized to maintenance or no maintenance. Local side effects were significant in 50% of patients. Patients with CIS had fewer recurrences with maintenance therapy. Other studies demonstrated similar outcomes, with a general theme of increased local side effects with modest outcome improvement (Isaka et al, 1992; Sekine et al, 1994).
Combination chemotherapy and BCG was evaluated in prospective trials by several investigators. The EORTC reported a 46% complete response rate when a solitary marker tumor was intentionally not resected and patients were subsequently given sequential MMC and BCG (van der Meijden et al, 1996). In a study of 188 patients with Ta and T1 lesions, no difference was seen with regard to recurrence, progression, or side effects in those patients treated with BCG and MMC compared with those treated with MMC alone. There was actually a significantly longer disease-free interval in the BCG monotherapy arm (55%) compared with the same combination arm (45%) in another study of 314 patients (Malmstrom et al, 1999; Solsona et al, 2002). Thus no clear advantage is obtained with sequential therapy, combination chemotherapy, or chemotherapy and BCG regimens using any of the combinations explored to date (Rintala et al, 1995, 1996; Witjes et al, 1998; Nieder et al, 2005).
Key Points: Intravesical Chemotherapy
Management of Refractory High-Grade Disease
Recurrent or persistent disease after an initial 6-week course of BCG has been traditionally referred to as BCG failure, although this term has been poorly defined in the past. Current consensus is that persistent disease after BCG therapy can be categorized as BCG refractory (nonimproving or worsening disease despite BCG), BCG resistant (recurrence or persistence of lesser degree, stage, or grade after an initial course, which then resolves with further BCG), or BCG relapsing (recurrence after initial resolution with BCG). BCG-refractory patients in particular are an especially high-risk group and should be strongly considered for immediate cystectomy if young and in generally good health (Herr and Dalbagni, 2003). Intravesical treatment should be reserved for patients refusing or too ill to undergo cystectomy, or on defined investigational protocols.
The necessity of biopsy to determine BCG response is unclear, although it should be strongly considered in high-risk patients to determine disease status at this key point in time. Urine cytology can be useful in this setting. Dalbagni and colleagues (1999) reported minimal utility in routine biopsy after BCG if cystoscopy and urinary cytology were both negative. Whereas 5 of 11 patients with erythematous bladder mucosa and positive cytology had positive bladder biopsies, none of 37 with erythematous lesions and negative cytology was positive, and only 1 in 13 patients with a normal mucosa had positive biopsies (Dalbagni et al, 1999). Other studies have suggested that the value of routine post-BCG biopsy is limited (Dalbagni et al, 1999). UroVysion FISH (Abbott Molecular, Chicago) conversion from positive to negative has been shown to correlate with BCG response in single-center studies (Kipp et al, 2005; Whitson et al, 2009).
Declaring failure may take up to 6 months because the response rate for patients with high-grade bladder cancer treated with BCG rose from 57% to 80% between 3 and 6 months after therapy. Clearly, the tumoricidal activity continued for some period after cessation of therapy. This has obvious implications not only for declaring BCG failure and the need for subsequent therapy but also for interpretation of success rates of salvage protocols if administered soon after therapy (Herr and Dalbagni, 2003).
Although most urologists will administer an initial 6-week course of intravesical therapy for high-risk patients (most likely involving BCG in North America and chemotherapy in Europe), management of patients with persistent disease after the first course is more complex. Such patients are at increased risk of progression, which is particularly likely in the event of early recurrence, progression while on therapy, or multiple recurrences.
If the initial treatment was chemotherapy, a course of BCG should be considered. BCG has demonstrated superiority to repeat courses of chemotherapy in this setting because the latter will lead to only an approximately 20% disease-free survival (Malmstrom et al, 1999; Steinberg et al, 2000). For patients who have failed BCG, a second course still gives a 30% to 50% response (Pansadoro and De Paula, 1987; Brake et al, 2000). Patients who cannot tolerate BCG for any reason may be considered for salvage chemotherapy, but the risk of failure and progression is high.
Further courses of BCG or chemotherapy beyond two are not recommended because they will fail 80% of the time. Rapid disease progression is common in such patients, so salvage chemotherapy, investigational protocols, and interferons alone or in combination with reduced doses of BCG may only be appropriate for patients who are unwilling or unable to undergo surgery even after being informed of their risks (Catalona et al, 1987).
The combination of IFN-α with BCG is expensive and has not been shown superior to BCG alone in primary therapy, so it has been used mostly for BCG failures. Small single-institution studies using low-dose BCG (typically one-third dose) plus 50 to 100 million units of IFN-α have demonstrated 1- to 2-year success rates of 50% to 60%, with better results with a second reinduction option and three sets of 3-week miniseries maintenance treatments 3, 9, and 15 months later (O’Donnell et al, 2001; Lam et al, 2003; Punnen et al, 2003). A large national multicenter phase 2 trial of combination BCG plus IFN-α in BCG-naïve and BCG-failure patients revealed similar findings (O’Donnell et al, 2004). Estimates for freedom from disease at 2 years were 57% for BCG-naïve patients and 42% for BCG-failure patients. Progression was seen in only 8% of patients in each group, suggesting this combination has a potential role regardless of prior BCG response.
Role of “Early” Cystectomy
Despite local therapy, many cases of high-grade non–muscle-invasive bladder cancer will progress to invasion and risk of cancer death. Although the initial response rate to BCG therapy in CIS patients can be above 80%, those patients who fail have a 50% chance of disease progression and potential for disease-specific mortality (Catalona et al, 1987; Nadler et al, 1994). Early (3-month) failure for T1 tumors after BCG is associated with an 82% progression rate, compared with a 25% progression rate in patients who do not fail at 3 months (Herr et al, 1997, 2000b). Up to 20% of patients with CIS will die of UC within 10 years (Herr et al, 1989), and each occurrence of T1 tumors is associated with a 5% to 10% chance of metastasis (Herr and Sogani, 2001), and residual tumor found on repeat resection in these patients is associated with an 82% chance of developing muscle invasion (Herr et al, 1997). These data offer compelling evidence of the potential to underestimate disease status in high-risk patients.
Cookson and coworkers (1997) reported that 27% of high-risk patients treated initially with aggressive intravesical therapy did well and died of other causes, and the same low number survived with an intact, functioning bladder 15 years after diagnosis. However, approximately half of patients experienced progression, and one third died of their disease. In contrast, patients who undergo immediate cystectomy for clinical T1 tumors benefit from more accurate pathologic staging in addition to a 10-year disease-free survival of 92%, compared with 64% with those with clinical T1 tumors who were found to actually have muscle invasion at the time of cystectomy (Bianco et al, 2004).
Despite the benign connotation of the term superficial formerly applied, up to 50% of patients with presumed non–muscle-invasive high-grade disease who undergo cystectomy will actually be found to have muscle-invasive disease. Such procedures have traditionally been termed early cystectomy on the basis of the fact that they are performed before the traditional surgical indication of documented detrusor muscle invasion. Considering that up to 15% will already have micrometastases (Chang and Cookson, 2005) and that a delay in cystectomy of even 12 weeks is associated with poorer survival, some of these procedures do not seem to be “early” enough (Sanchez-Ortiz et al, 2003).
The risk of progression must be weighed against the risk, morbidity, and impact on quality of life for cystectomy. Thus a reasonable goal might be, as termed by Chang and Cookson (2005), “timely” cystectomy for patients at risk.
Ten-year survival after cystectomy for non–muscle-invasive cancer can range from 67% to 92% (Amling et al, 1994; Freeman et al, 1995). However, despite the bias that substantial progression can be averted with the benefit of early detection and close surveillance in patients whose tumors are identified before muscle invasion, it appears that such patients who progress to muscle invasion have a poorer prognosis than do those who initially present with muscle-invasive disease (Schrier, 2004; Lee et al, 2007). Thus overconfidence in disease control status with high-risk patients on surveillance creates a false sense of security.
The AUA Guidelines Panel listed cystectomy as the first option for patients with refractory disease after an initial course of intravesical therapy (see later). Nevertheless, fewer than one in five American urologists surveyed stated that they would recommend cystectomy for their patients with CIS refractory to two courses of intravesical BCG, a group with an 80% risk of failure or progression (Joudi, 2006). Cystectomy in that setting, or for persistent high-grade papillary disease after two courses of intravesical therapy, is the standard of care and should not be considered “early.”
Retrospective data in most series suggest that tumor markers such as P53 and RB may be useful for stratifying high-risk patients in the future. High-risk P53 lesions have a 75% progression rate, compared with 25% in P53-negative lesions. Survival is 60% at 10 years in patients with P53-positive lesions, whereas it is 88% in patients with P53-negative lesions (Sarkis et al, 1993). Grossman and colleagues (1998) found that for T1 lesions evaluated for P53 and RB, progression at 5 years was 30% if either marker was positive and 47% if both markers were positive. No progression was noted in lesions that were wild type for both markers (Grossman et al, 1998). Although P53 positivity did not predict response for BCG-treated patients in another study, post-BCG P53-positive expression was a marker of tumor progression (P53 positive, 82% progression and 41% mortality; P53 negative, 13% progression and 7% mortality) (Lacome et al, 1996). Other studies have refuted these findings, so the role of P53 for the prediction of tumor behavior and response to therapy remains under debate (Peyromaure et al, 2002).
The role of surgical approaches involving potential oncologic concessions such as seminal and nerve-sparing cystectomy in such patients theoretically at lower risk of recurrence compared with patients with muscle invasion remains unknown (Hautmann and Stein, 2005). The availability of neobladder for less disfiguring urinary diversion has been reported to decrease the delay in treatment of such patients, potentially leading to significantly improved disease-free survival (Hautmann, 1998).
Critical evaluation of partial cystectomy for non–muscle-invasive bladder cancer is limited, although the practice is common (up to 20% of patients treated with extirpative therapy in the United States) in patients with muscle invasion (Hollenbeck et al, 2005). Holzbeierlein and colleagues (2004) reported that 6.9% of the patients presenting to Memorial Sloan-Kettering Cancer Center for surgical management of bladder cancer underwent partial cystectomy (29% of whom did so for clinical non–muscle-invasive disease). Five-year survival was 69%, and two thirds of patients were alive with an intact, functioning bladder. CIS was the most significant predictor of progression.
Partial cystectomy provides more accurate pathologic staging than does TURBT and allows lymphadenectomy. Appropriate candidates with non–muscle-invasive tumors would logically be the same as those for invasive cancer—those with solitary nonrecurring tumors at the dome or well away from the trigone and no CIS.
Cystectomy should also be considered in patients whose cancer cannot be reasonably controlled through resection: bulky tumors, inaccessible due to a large bladder or urethral stricture disease, or otherwise not amenable to safe removal endoscopically.
In summary, radical cystectomy offers the most accurate pathologic staging option and should be strongly considered for patients with non–muscle-invasive bladder cancers that are high grade and invading deeply into lamina propria, exhibit lymphovascular invasion, are associated with diffuse CIS, are in diverticula, substantially involve the distal ureters or prostatic urethra, are refractory to initial therapy, or are too large or anatomically inaccessible to remove in their entirety endoscopically. It can also be used in patients who understand the risks and benefits of bladder preservation versus cystectomy and request definitive therapy (Stein, 2003). Partial cystectomy suffers from limited data but might be a promising bladder preservation option situated between the extremes of TURBT combined with intravesical therapy and radical cystectomy.
Role of Alternative Options for Refractory Disease
Photodynamic therapy (PDT) is performed by administering a photosensitizing agent such as porfimer sodium (Photofrin) systemically or hexaminolevulinate (HAL) intravesically. Two to 3 days after the substance has cleared from the normal tissue (for Photofrin), the patient is given an intravesical treatment with red laser light (630 nm) for 12 to 20 minutes. Intravesical intralipid allows for more uniform distribution of laser light (Manyak et al, 1990). After excitation by light the photosensitizer reacts with molecular oxygen to form free radicals and reactive singlet oxygen, which are cytotoxic.
The response rate in CIS patients from combined series is 66%, with a duration of 37 to 84 months (Jocham et al, 1989; Nseyo et al, 1997, 1998; Walther, 2000). For patients with papillary disease, an overall response rate of 51% has been achieved with a median time to recurrence of 24 to 48 months (Naito et al, 1991; Nseyo et al, 1997, 1998; Walther, 2000). PDT has been limited by significant side effects such as bladder contracture or irritability (50%) and dermal sensitivity (19%) (Naito et al, 1991; Uchibayashi et al, 1995; Nseyo et al, 1997, 1998).
Research efforts have been directed at development of improved photosensitizers and modifications in laser dosimetry (Kriegmair et al, 1996a; Nseyo et al, 1997, 1998). A leading candidate for photosensitization is HAL, a more lipophilic ester of 5-ALA, which generates a sensitizer called protoporphyrin IX that appears more tumor specific, although clinical data are limited (Datta et al, 1998). Preclinical studies using hypericin show promise (Kamuhabwa, 2004).
Radiation therapy in the treatment of non–muscle-invasive bladder cancer is generally restricted to those individuals who refuse cystectomy after the failure of intravesical therapy or who are unsuitable for major surgery (Kim, 2000). A complete response to radiation therapy and TUR is attainable in 50% to 75% of patients, but the additional benefit of radiation to TUR remains unclear (DeNeve et al, 1992; Rozan et al, 1992; Jansson et al, 1998). Five-year response rates are 44% to 60%. There is no significant effect on CIS. Due to reports that up to 50% of patients will develop progression and a high likelihood of death (Rödel, 2001), there is a limited role for radiation therapy other than for palliative purposes in this population.
Key Points: Management of Refractory Disease
Surveillance and Prevention
Although bladder cancer is less common than prostate cancer, expenditures are almost twice as high for bladder cancer due to its chronic nature and the need for long-term surveillance. According to the Agency for Health Care Policy and Research, annual expenditures are $2.2 billion for bladder cancer versus $1.4 billion for prostate cancer (Donat, 2003). A significant portion of this cost is due to surveillance (Hedelin et al, 2002).
Surveillance strategies for UC recurrence have historically relied on the diagnostic combination of cystoscopy and urinary cytology. In clinical practice, only 40% of patients actually comply with a standard surveillance protocol (Schrag et al, 2003). Most protocols include this combination every 3 months for 18 to 24 months after the initial diagnosis, then every 6 months for the following 2 years, and then annually, resetting the clock with each newly identified tumor (Fitzpatrick, 1993). Although the accuracy of both tests relies on subjective and operator-dependent interpretation of visible findings, their traditional presumed status as the “gold standard” has been widely accepted (Brown, 2000).
Cystoscopic Surveillance
Office-based cystoscopy offers rapid, relatively painless visual access to the urothelium. Papillary tumors are readily identified arising from the smooth bladder surface. CIS is classically described as a velvety red mucosal patch, although the reliability of such findings has been called into question.
The role of cystoscopy as a “gold standard” in cancer detection has come under scrutiny with the emergence of tumor markers and the development of newer endoscopic technology including fluorescence cystoscopy as described previously (Kriegmair et al, 1996a, 1996b, 1999; Filbeck et al, 1999). Nevertheless, for office-based diagnosis it allows identification of the site and characteristics of most tumors. There is a high positive predictive value with cystoscopy because most lesions believed to be malignant are proven so pathologically. The endoscopic appearance cannot reliably predict tumor stage or grade, although sessile morphology and/or the presence of necrosis suggest high-grade disease likely to be invasive.
Cystoscopy is usually performed in the outpatient setting. Rigid rod lens systems offer accurate visualization of the bladder. Flexible fiberoptic cystoscopes are almost as sensitive and are markedly more comfortable for men, although there is no clear advantage to their use in women because of the short, straight female urethra. Newer digital chip cystoscopes offer similar tolerability but better visualization due to clarity and magnification on video monitors. Complete visualization of the bladder mucosa is possible in a matter of seconds in most patients. Their high-resolution imaging obviates the only potential advantage of rigid cystoscopy (slightly better optics than fiberoptic flexible scopes). Thus flexible cystoscopy has essentially replaced rigid cystoscopy for surveillance in men in North America and may do so in women.
Using the same technology for flexible cystoscopy as described earlier for HAL fluorescence rigid cystoscopy, phase 2 studies have had mixed results but suggest that office-based fluorescence cystoscopy can improve the detection of CIS and papillary tumors (Witjes, 2004; Loidl, 2005).
The vast majority of both men and women tolerate office-based cystoscopy with minimal discomfort. Intraurethral injection of local anesthetics is almost universal among urologists despite a paucity of data to support the practice. Most studies and a meta-analysis (Patel et al, 2008b) have failed to identify benefit (Palit et al, 2003; Rodriguez-Rubio et al, 2004), and two recent studies actually found that pain experience was higher with the use of local anesthetics than in patients cystoscoped using aqueous lubricant alone (Ho et al, 2003; Chen et al, 2005). Considering the fact that anesthetic agents can partially cloud visualization, this ubiquitous practice should be reconsidered. Use of a video monitor allows the patient to see and understand the findings, theoretically distracting them from any discomfort. Men who are able to do so tolerate the procedure with approximately 50% less pain (VAS 2.21 vs. 1.31, P < .01) than those who cannot see their findings on the monitor (Patel et al, 2007). This has not been found to be of significant benefit in women for unclear reasons (Patel et al, 2008).
The bladder should be evacuated before cystoscopy. This removes concentrated amorphous detritus and radiographic contrast if studies were performed earlier in the day. Aspiration is occasionally necessary during the procedure using a 60-mL syringe attached to the irrigant port. This can further lessen clouding. A systematic approach is mandatory to ensure all urothelium is visualized.
Attempts to modify the previously described surveillance schedule have been made using decision analysis tools (Kent et al, 1989; Abel, 1993). Several authors recommend termination of surveillance at 5 or more years for low-risk patients (Haukaas et al, 1999). However, the actual cost of surveillance cystoscopy is responsible for only 13% of the expenditures for bladder cancer care in one study, so the financial opportunity may be limited for such efforts (Schoenberg et al, 2000; Hedelin et al, 2002). In addition, the risk of recurrence and potential for progression exists beyond this period. Reports of late recurrences of high-grade cancer years after the original tumor temper some authors’ enthusiasm with terminating surveillance at any point (Thompson et al, 1993; Morris et al, 1995; LeBlanc et al, 1999; Zieger et al, 2000). Thus there is no consensus on such programs.
Other investigators have examined the predictive impact of early or multiple recurrences and how this might affect surveillance (Parmar et al, 1989; Holmang et al, 1995; Reading et al, 1995). Tumor recurrence on initial 3-month cystoscopy and number of tumors on initial resection (single or multiple) provide the most predictive information with regard to recurrence in several studies. Absence of recurrence on the 3-month surveillance cystoscopy in patients with TaG1 tumors is associated with recurrence rates so low that annual cystoscopy appears safe even at that point (beginning 12 months after the initial resection (Fitzpatrick et al, 1986; Olsen and Genster, 1995; Frydenberg et al, 2005). Finally, patients with a negative cystoscopy and a negative UroVysion assay (see later) are at low risk of recurrence in the following 6 to 12 months, creating opportunity to individualize the surveillance schedule (Sarosdy et al, 2002).
Urine Cytology
Cytology involves microscopic evaluation of stained cellular smears from the urine. Unlike tumor markers, urinary cytology is not a laboratory test—it is a pathologist’s interpretation of the morphologic features of shed urothelial cells. Poor cellular cohesion in high-grade tumors, especially CIS, enhances the yield.
Its high specificity is the most important feature of cytology because a positive reading regardless of cystoscopic or radiographic findings suggests the existence of malignancy in the vast majority of patients. Even in the setting of UC patients with a negative workup (cystoscopy and upper tract imaging) with a persistently positive cytology, 40% were found to have genitourinary cancer within 24 months, with a mean time to diagnosis of 5.6 months (Nabi, 2004).
Bladder irrigation or barbotage increases the cellularity available for evaluation compared with voided urine. Nevertheless, Murphy (1981) showed that urine collected cystoscopically before obtaining a bladder wash provided additional diagnostic information in their study of 313 patients. Bladder washings had a higher yield, but 13.1% of cancers would have been missed in bladder washings alone. Moreover, mechanical trauma has the potential to create cellular alterations that might interfere with interpretation. Radiographic contrast media have also been implicated in creating cellular shrinkage, nuclear pyknosis, fragmentation, and cytoplasmic vacuolization that might lead to a false-positive reading, especially when injected for retrograde ureteropyelography (McClennan et al, 1978). This may not be a concern when low osmolar, ionic and nonionic, contrast media are used (Andriole et al, 1989).
Although cytology has traditionally been believed to have high sensitivity for high-grade cancer, recent studies do not support this. When Mayo Clinic researchers reviewed laboratory findings, they observed that only 58% of bladder tumors were identified using cytology. Its sensitivity was not limited to low-grade tumors because only 71% of high-grade cancers were identified. Because this was lower than expected, they subsequently reviewed the literature and found that cumulative data from series published after 1990 reported that cytology actually identified (using the older grading system) 11% of grade 1, 31% of grade 2, and only 60% of grade 3 tumors (Halling et al, 2000). In contrast, they observed that these recent findings were well below those reported before 1990, when the sensitivity of cytology was 94% for grade 3 tumors, but could find no explanation for this deterioration. These findings are supported by numerous other studies and emphasized by a recent multicenter study involving several institutions noted for bladder cancer expertise that found cytology had an overall sensitivity of 15.8% (Grossman, 2005).
Thus cytology has high specificity but low sensitivity for both high-grade and low-grade tumors including CIS in recently published reports.
Tumor Markers
Many attempts have been made to develop a UC biomarker test to complement or replace urinary cytology (Table 81–7). Most of these have had adequate sensitivity but poor specificity, resulting in substantial false-positive readings, creating the need for further diagnostic testing. Current urinary markers have been developed to detect tumor-associated antigens, blood group antigens, growth factors, cell cycle/apoptosis, and extracellular matrix proteins. The most significant issue limiting widespread adoption of tumor markers is the lack of prospective data to support their impact on prognosis or disease management (Lokeshwar et al, 2005). They are considered alphabetically as follows.
The qualitative point-of-care test BTA stat (Polymedco, Inc., Cortlandt Manor, NY) and the quantitative BTA TRAK (Polymedco) assays detect human complement factor H–related protein. The overall sensitivity of these tests ranges from 50% to 80%, whereas the specificity is between 50% and 75%. These tests are more sensitive than cytology but can be falsely positive in patients with inflammation, infection, or hematuria (Liou, 2006).
ImmunoCyt (DiagnoCure, Inc., Saint Foy, Canada) is a hybrid of cytology and an immunofluorescent assay. Three fluorescent-labeled monoclonal antibodies are targeted at a UC variant of carcinoembryonic antigen and two bladder mucins. Sensitivity and specificity are reported to be 86% and 79%, respectively. It has not been shown to be affected by benign conditions, but interpretation is complex and operator dependent (Toma, 2004; Tetu, 2005).
The NMP22 BladderChek Test (Matritech, Inc., Newton, MA) is based on the detection of nuclear matrix protein 22, part of the mitotic apparatus released from urothelial nuclei upon cellular apoptosis. The protein is elevated in UC, but it is also released from dead and dying urothelial cells. Benign conditions of the urinary tract such as stones, infection, inflammation, hematuria, and cystoscopy can cause a false-positive reading. Both a laboratory-based, quantitative immunoassay and a qualitative point-of-care test are available. The sensitivities and specificities range from 68.5% to 88.5% for sensitivity and from 65.2% to 91.3% for specificity (Liou, 2006). A multi-institutional trial involving 1331 patients showed that, overall, the NMP22 was more sensitive than cytology but less specific. Sensitivities were 50% and 90% for noninvasive and invasive cancer, respectively, with an overall sensitivity of 55.7%. Overall specificity was higher for cytology at 99.2% compared with NMP22 at 85.7%. The sensitivity of cystoscopy in this study was 88.6%, but when combined with NMP22 this increased to 93.7% (Grossman, 2005).
UroVysion (Abbott Molecular, Chicago) is a cytology-based test that uses FISH of DNA probes or “labels” specifically chosen to identify certain chromosomal foci. Probes to identify aneuploidy of chromosomes 3, 7, and 17 are combined with a probe to the 9p21 locus. Probes can be developed to identify essentially any locus, but this combination has the best sensitivity and specificity (Halling et al, 2000). Cumulative data from comparative studies show sensitivity for cytology compared with FISH of 19% versus 58% for grade 1, 50% versus 77% for grade 2, and 71% versus 96% for grade 3. Similar findings occurred by stage where cytology compared with FISH sensitivity was 35% versus 64% for Ta, 66% versus 83% for T1, and 76% versus 94% for muscle-invasive carcinoma (Jones, 2006).
Notably, cytology detected only 67% of cases with CIS versus 100% detection by FISH in comparative studies. UroVysion has the highest specificity of the available tumor markers. It will, however, detect chromosomal changes before the development of phenotypic expression of malignancy, so it leads to an “anticipatory positive” reading in some patients. Such readings are often not false positives and will lead to identification of clinical tumors within 3 to 15 months in the majority of cases (Sarosdy et al, 2002). Moreover, patients testing negative are unlikely to experience tumor recurrence in less than 1 year (Yoder et al, 2007). This may allow identification of patients at risk of recurrence versus those unlikely to recur in order to individualize surveillance protocols.
UroVysion has also been shown to clarify equivocal findings in patients with atypical or negative cytology (Skacel, 2003). It is not affected by hematuria, inflammation, or other factors that can cause false-positive readings with some tumor markers, so it appears to be useful as a marker of BCG response (Kipp et al, 2005; Whitson et al, 2009).
Determining the utility of tumor markers and the choice of which one to use is not clear at this time. For example, if indication for biopsy in the operating room is the end point, then high specificity is desired to limit the number of negative biopsies. On the other hand, if increasing the interval of cystoscopic surveillance is the end point, then high sensitivity, particularly for high-grade tumors, is desired. Defining that a patient has a low likelihood of recurrence within the following year can allow individualization of surveillance protocols (Fig. 81–8) (Grossman et al, 2006).

Figure 81–8 An abnormal enlarged cell (lower right) demonstrates three copies of chromosome 3 (red), chromosome 7 (green), and chromosome 17 (aqua) using fluorescence in situ hybridization. Homozygous deletion of band 9p21 locus (yellow) is also present.
(Courtesy of Raymond Tubbs, MD; Department of Laboratory Pathology, Cleveland Clinic Foundation.)
Extravesical Surveillance
The proportion of patients developing upper tract UC after treatment of non–muscle-invasive disease has been reported as 0.002% to 2.4% over intervals of 5 to 13 years (Shinka et al, 1988; Oldbring et al, 1989; Holmang et al, 1995; Sadek et al, 1999), although the risk increases substantially over time to as high as 18% in very high-risk populations (Herr et al, 1997). Synchronous tumors were detected in none of 78 patients (0%) with grade 1 (using the prior grading system) tumors, 4 of 361 (1.1%) with grade 2, and 5 of 360 (1.3%) with grade 3, as well as 0% for low-grade Ta and 7% for T1 (Herranz-Amo et al, 1999). Most patients will require upper tract imaging specifically for the indication of hematuria. A recent report from the Surveillance Epidemiology and End Results (SEER) database showed that only 0.8% of bladder cancer patients develop subsequent upper tract tumors, so surveillance is of limited value unless the patient has hematuria or a high-grade tumor near the ureteral orifice (Wright et al, 2009). In a review of 591 patients with median follow-up of 86 months, upper tract recurrence was 0.9% in low-risk patients (solitary, low-grade, low-stage Ta/T1), 2.2% in patients at intermediate risk (recurrent or multifocal disease), and 9.8% in high-risk patients including intravesical chemotherapy failures (Hurle et al, 1998). Most reviews have concluded that patients who have high-grade or multiple tumors should undergo upper tract imaging on the basis of the risk of upper tract disease, but those with low-grade tumors probably do not benefit from imaging at the time of bladder cancer diagnosis.
The proper study to evaluate the upper tract is debatable. Excretory urography is the traditional choice but gives limited information about renal parenchyma and can miss small tumors. Retrograde ureteropyelography requires instrumentation, but this is often not a problem because these patients require removal of the primary bladder tumor, so the procedures can be combined. Computed tomography (CT) urography is a promising technology for the evaluation of hematuria, but its role in the evaluation of patients with non–muscle-invasive bladder cancer has not been extensively reported (Herts, 2003).
Although infrequent, the appearance of upper tract disease is associated with mortality rates of 40% to 70%. Patients with high-risk disease treated with BCG experience upper tract recurrence risk of 13% to 18% (Miller et al, 1993; Herr et al, 1997). The risk for recurrence in this population appears greatest over the first 5 years after treatment (median time to detection, 56 months) yet persists at least 15 years.
Selective cytology of the upper tract may increase the yield of upper tract lesions detected, but, in the presence of a bladder tumor, selective upper tract cytology may be falsely positive and is not recommended for most patients (Zincke et al, 1983; Sadek et al, 1999).
Secondary tumor involvement of the prostatic urethra and ducts by UC may be detected in 10% to 15% of patients with high-risk non–muscle-invasive disease within 5 years and in 20% to 40% within 10 years (Donat, 2003). Patients who have refractory disease are at risk for extravesical recurrence in the prostatic fossa in approximately one third of cases, 44% of which are fatal (Herr et al, 1988).
In summary, surveillance strategies should be individualized on the basis of the risk of recurrence in the bladder and extravesical sites (Table 81–8).
Secondary Prevention Strategies
Both lifestyle changes and chemoprevention could potentially reduce the risk of recurrence and should be considered in the comprehensive management of patients with non–muscle-invasive disease. Unlike primary prevention, secondary prevention seeks to prevent recurrent tumors in patients who already carry a diagnosis of a specific cancer. Although this may also involve minimizing exposure to carcinogens, it relies more heavily on optimizing host responses and creating an environment that can retard tumor growth.
Lifestyle changes are particularly important because UC is directly linked to environmental factors in the majority of cases. Smoking cessation, increased fluid intake, and a low-fat diet may all reduce the risk of recurrence, with the former being of paramount importance. Increased hydration reduces the concentration and dwell time of carcinogens and thereby reduces the risk of malignant transformation within the urothelium (Jiang, 2008). The Physician Health Study showed an inverse correlation between fluid intake and the incidence of UC on longitudinal follow-up, but this simple measure may also be of benefit for secondary prevention for patients who already have a history of UC (Michaud et al, 1999). High fat and cholesterol intake are now firmly established as risk factors for many cancers and UC is no exception, although the mechanisms are not as well defined as for other malignancies (Steineck et al, 1990).
A variety of agents have been investigated for chemoprevention strategies for patients with UC and, although not clinically fruitful to date, this remains an active area of investigation. Retinoids including vitamin A and its analogs have been studied most intensively. These agents enhance differentiation of normal and neoplastic cells and appear to have antioxidant and immunostimulatory properties. Whereas animal studies for preventing UC were promising, studies looking at primary prevention in humans were conflicting and the side effects of these agents were problematic in this long-term prophylactic setting (Sporn et al, 1977; Becci et al, 1978; Eichholzer et al, 1996; Steinmaus et al, 2000). Synthetic retinoids with the potential for reduced toxicity have been tested in patients with known UC. However, fenretinide failed to reduce recurrence rates when compared with placebo, and 3 patients (12%) in the etretinate arm of another randomized study were found to have myocardial infarctions, although this may have been coincidental (Studer et al, 1995; Decensi et al, 2000; Lerner et al, 2005). Etretinate delayed the time to second recurrence but had no effect on time to first recurrence, and potential cardiac risk was of concern.
Pyridoxine (vitamin B6) breaks down tryptophan metabolites in the urine that may induce UC, but clinical studies have been conflicting (Byar and Blackard, 1977; Newling et al, 1995). Difluoromethylornithine (DFMO), which inhibits the enzyme ornithine decarboxylase that contributes to malignant transformation, was also studied recently in patients with non–muscle-invasive UC (Messing et al, 2005). However, recurrence rates for this agent were not reduced when compared with placebo and enthusiasm has thus waned.
The most promising data for secondary chemoprevention of UC relate to the use of high doses of multivitamins. One small but important study randomized 65 patients with noninvasive UC to either a recommended daily allowance (RDA) multivitamin or megadose vitamins with augmented levels of vitamins A, B6, C, and E (Lamm et al, 1994). Comparison of the two regimens revealed no difference in recurrence rates in the first year; however, there was a statistically significant advantage for the megadose group when the 5-year recurrence rates were calculated. At this point, 80% of patients in the RDA group had experienced recurrence compared with only 40% in the megadose group. These findings suggest that the beneficial effect of megadose vitamins is related to its suppressive effect on partially transformed cells within the urothelium rather than inhibiting early recurrences, which are typically caused by tumor cell implantation or incomplete resection. Confirmation of these findings by larger prospective trials is necessary.
Ongoing phase 3 trials for patients with noninvasive UC are evaluating the potential chemopreventive roles of celecoxib (a cyclooxygenase-2 inhibitor), erlotinib (an epidermal growth factor receptor inhibitor), and green tea extracts.
Key Points: Surveillance and Prevention
Table 81–9 American Urological Association 2007 Guidelines for Non–Muscle-Invasive Bladder Cancer
| Index Patient #1: Abnormal Urothelial “Growth” but Not Proven Cancer |
| Index Patient #2: Small-Volume, Low-Grade Ta |
| Index Patient #3: Multifocal or Large Low-Grade Ta, or Recurrent Low-Grade Ta |
| Index Patient #4: High-Grade Ta, T1, or CIS |
| Index Patient #5: High-Grade Ta, T1, and/or CIS Following Prior Intravesical Therapy |
BCG, bacillus Calmette-Guérin; CIS, carcinoma in situ; MMC, mitomycin C.
From Hall MC, Chang SS, Dalbagni G, et al. Guideline for the management of non-muscle invasive bladder cancer (stages Ta, T1, and Tis): 2007 update. J Urol 2007;178:2314.
Chang SS, Cookson MS. Radical cystectomy for bladder cancer: the case for early intervention. Urol Clin North Am. 2005;32:147-155.
Epstein JI, Amin MB, Reuter VR, Mostofi FK. The World Health Organization/International Society of Urological Pathology consensus classification of urothelial (transitional cell) neoplasms of the urinary bladder. Bladder Consensus Conference Committee. Am J Surg Pathol. 1998;22:1435-1448.
Hall MC, Chang SS, Dalbagni G, et al. Guideline for the management of non-muscle invasive bladder cancer (stages Ta, T1, and Tis): 2007 update. J Urol. 2007;178(6):2314-2330.
Koch MO, Smith JAJr. Natural history and surgical management of superficial bladder cancer (stages Ta/T1/Tis). In: Vogelzang N, Miles BJ, editors. Comprehensive textbook of genitourinary oncology. Baltimore: Williams & Wilkins; 1996:405-415.
Lamm DL, Blumenstein BA, Crissman JD, et al. Maintenance bacillus Calmette-Guérin immunotherapy for recurrent Ta,T1 and carcinoma in situ TCC of the bladder: a randomized SWOG study. J Urol. 2000;163:1124-1129.
O’Donnell MA. Practical applications of intravesical chemotherapy and immunotherapy in high-risk patients with superficial bladder cancer. Urol Clin North Am. 2005;32:121-131.
Soloway MS. Introduction (and entire supplement). Urology. 66(6S1), 2005.
Sylvester RJ, Oosterlinck W, van der Meijden AP. A single immediate postoperative instillation of chemotherapy decreases the risk of recurrence in patients with stage Ta, T1 bladder cancer: a meta-analysis of published results of randomized clinical trials. J Urol. 2004;171:2186-2190.
Abel PD. Follow-up of patients with “superficial” transitional cell carcinoma of the bladder: the case for a change policy. Br J Urol. 1993;72:135-142.
Althausen AF, Prout GRJr, Daly JJ. Non-invasive papillary carcinoma of the bladder associated with carcinoma in situ. J Urol. 1976;116:575-580.
Amling C, Thraser J, Frazier H, et al. Radical cystectomy for stages Ta, Tis, and T1 transitional cell carcinoma of the bladder. J Urol. 1994;151:31.
Andriole GL, McClennan BL, Becich MJ, Picus DD. Effect of low osmolar, ionic and nonionic, contrast media on the cytologic features of exfoliated urothelial cells. Urol Radiol. 1989;11:133-135.
Au JL, Badalament RA, Wientjes MG. International Mitomycin C Consortium. Methods to improve efficacy of intravesical mitomycin C: results of a randomized phase III trial. J Natl Cancer Inst. 2001;93:597-604.
Badalament RA, Herr HW, Wong GY, et al. A prospective randomized trial of maintenance versus nonmaintenance intravesical bacillus Calmette-Guérin therapy of superficial bladder cancer. J Clin Oncol. 1987;5:441-449.
Balbay MD, Cimentepe E, Unsal A, et al. The actual incidence of bladder perforation following transurethral bladder surgery. J Urol. 2005;174:2260-2262.
Bassi P, Spinadin R, Carando R, et al. Modified induction course: a solution to side-effects? Eur Urol. 2000;37(Suppl. 1):31-32.
Bayraktar Z, Gurbuz G, Tasci AI, Sevin G. Management of clinical T1 bladder transitional cell carcinoma by radical cystectomy. Urol Oncol. 2004;22:290-294.
Becci PJ, Thompson HJ, Grubbs CJ, et al. Inhibitory effect of 13-cis-retinoic acid on urinary bladder carcinogenesis induced in C57BL/6 mice by N-butyl-N-(4-hydroxybutyl)-nitrosamine. Cancer Res. 1978;38:4463-4466.
Beer M, Joeham D, Beer A. Adjuvant laser treatment of bladder cancer: 8 years’ experience with the Nd:YAG laser. Br J Urol. 1989;63:476-478.
Beisland HO, Seland O. A prospective randomized study on Nd:YAG laser irradiation versus TUR in the treatment of urinary bladder cancer. Scand J Urol Nephrol. 1986;20:209-212.
Belldegrun AS, Franklin JR, O’Donnell MA, et al. Superficial bladder cancer: the role of interferon-alpha. J Urol. 1998;159:1793-1801. Review. Erratum in J Urol 1998;160:1444
Benson RC. Laser treatment. In: Smith JAJr, editor. High tech urology: technologic innovations and their clinical applications. Philadelphia: WB Saunders; 1992:47-79.
Bercovich E, Deriu M, Manferrari F, Irianni G. BCG vs. BCG plus recombinant alpha-interferon in superficial tumors of the bladder. Arch Ital Urol Androl. 1995;67:257-262.
Berrum-Svennung I, Granfors T, Jahnson S, et al. A single instillation of epirubicin after transurethral resection of bladder tumors prevents only small recurrences. J Urol. 2008;179(1):101-105.
Bianco FJJr, Justa D, Grignon DJ. Management of clinical T1 bladder transitional cell carcinoma by radical cystectomy. Urol Oncol. 2004;22:290-294.
Bittard H, Lamy B, Billery C. Clinical evaluation of cell deoxyribonucleic acid content measured by flow cytometry in bladder cancer. J Urol. 1996;155:1887-1891.
Bohle A, Bock PR. Intravesical bacille Calmette-Guérin versus mitomycin C in superficial bladder cancer: formal meta-analysis of comparative studies on tumor progression. Urology. 2004;63:682-686.
Bohle A, Brandau S. Immune mechanisms in bacillus Calmette-Guérin immunotherapy for superficial bladder cancer. J Urol. 2003;170:964-969.
Bouffioux C, Kurth KH, Bono A, et al. Intravesical adjuvant chemotherapy for superficial transitional cell bladder carcinoma: Results of 2 European Organization for Research and Treatment of Cancer randomized trials with mitomycin C and doxorubicin comparing early versus delayed instillations and short-term versus long-term treatment. J Urol. 1995;153:934.
Brake M, Loertzer H, Horsch R. Long-term results of intravesical bacillus Calmette-Guérin therapy for stage T1 superficial bladder cancer. Urology. 2000;55:673-678.
Brausi M, Collette L, Kurth K, et al. Variability in the recurrence rate at first follow-up cystoscopy after TUR in stage Ta, T1 transitional cell carcinoma of the bladder: a combined analysis of seven EORTC studies. EORTC Genito-Urinary Tract Cancer Collaborative Group. Eur Urol. 2002;41:523-531.
Bretton PR, Herr HW, Kimmel M, et al. The response of patients with superficial bladder cancer to a second course of intravesical bacillus Calmette-Guérin. J Urol. 1990;143:710-712.
Brosman SA. Experience with bacillus Calmette-Guérin in patients with superficial bladder carcinoma. J Urol. 1982;128:27-30.
Brown FM. Urine cytology: is it still the gold standard for screening? Urol Clin North Am. 2000;27:25-37.
Byar D, Blackard C. Comparisons of placebo, pyridoxine, and topical thiotepa in preventing recurrence of stage I bladder cancer. Urology. 1977;10:556-562.
Calabro F, Sternberg CN. New drugs and new approaches for the treatment of metastatic urothelial cancer. World J Urol. 2002;20:158-166.
Catalona WJ, Hudson MA, Gillen DP. Risks and benefits of repeated courses of intravesical bacillus Calmette-Guérin therapy for superficial bladder cancer. J Urol. 1987;137:220-224.
Chang R, Marshall FF, Mitchell S. Percutaneous management of benign ureteral strictures and fistulas. J Urol. 1989;137:1126.
Chang SS, Cookson MS. Radical cystectomy for bladder cancer: the case for early intervention. Urol Clin North Am. 2005;32:147-155.
Chen YT, Hsiao PJ, Wong WY, et al. Randomized double-blind comparison of lidocaine gel and plain lubricating gel in relieving pain during flexible cystoscopy. J Endourol. 2005;19:163-166.
Collado A, Chechile GE, Salvador J, Vicente J. Early complications of endoscopic treatment for superficial bladder tumors. J Urol. 2000;164:1529-1532.
Cookson MS, Herr HW, Shang ZF, et al. The treated natural history of high risk superficial bladder cancer: 15 year outcome. J Urol. 1997;158:62-67.
Cookson MS, Sarosdy MJ. Management of stage T1 superficial bladder cancer with intravesical bacillus Calmette-Guérin. J Urol. 1992;148:797-801.
Coplen DE, Marcus MD, Myers JA, et al. Long-term follow-up of patients treated with 1 or 2, 6-week courses of intravesical bacillus Calmette-Guérin: analysis of possible predictors of response free of tumor. J Urol. 1990;144:652-657.
Cote R, Chatterjee SJ. Molecular determinants of outcome in bladder cancer. Cancer J Sci Am. 1999;5:1-15.
Dalbagni G, Rechtschaffen T, Herr HW. Is transurethral biopsy of the bladder necessary after 3 months to evaluate response to bacillus Calmette-Guérin therapy? J Urol. 1999;162:708-709.
Datta SN, Loh CS, MacRobert AJ, et al. Quantitative studies of the kinetics of 5-aminolaevulinic acid–induced fluorescence in bladder transitional cell carcinoma. Br J Urol. 1998;78:1113-1118.
Decensi A, Torrisi R, Bruno S, et al. Randomized trial of fenretinide in superficial bladder cancer using DNA flow cytometry as an intermediate end point. Cancer Epidemiol Biomarkers Prev. 2000;9:1071-1078.
Degtyar P, Neulander E, Zirkin H, et al. Fluorescence in situ hybridization performed on exfoliated urothelial cells in patients with transitional cell carcinoma of the bladder. Urology. 2004;63:398-401.
DeJager R, Guinan P, Lamm DL, et al. Long-term complete remission in bladder carcinoma in situ with intravesical TICE bacillus Calmette-Guérin: overview analysis of six phase II clinical trials. Urology. 1991;38:507-513.
DeNeve W, Lybeert ML, Goor C, et al. T1 and T2 carcinoma of the urinary bladder: long-term results with external, preoperative, or interstitial radiotherapy. Int J Radiat Oncol Biol Phys. 1992;23:299-304.
Denzinger S, Burger M, Walter B, et al. Clinically relevant reduction in risk of recurrence of superficial bladder cancer using 5-aminolevulinic acid-induced fluorescence diagnosis: 8-year results of prospective randomized study. Urology. 2007;69(4):675-679.
Di Stasi SM, Giannantoni A, Stephen RL, et al. Intravesical electromotive mitomycin C versus passive transport mitomycin C for high risk superficial bladder cancer: a prospective randomized study. J Urol. 2003;170:777-782.
Di Stasi SM, Riedl C. Updates in intravesical electromotive drug administration of mitomycin-C for non-muscle invasive bladder cancer. World J Urol. 2009;27:325-330.
Donat SM. Evaluation and follow-up strategies for superficial bladder cancer. Urol Clin North Am. 2003;30:765-766.
Donat SM, North A, Dalbagni G, Herr HW. Efficacy of office fulguration for recurrent low grade papillary bladder tumors less than 0.5 cm. J Urol. 2004;171:636-639.
Droller MJ. Biological considerations in the assessment of urothelial cancer: a retrospective. Urology. 2005;66(5 Suppl.):66-75.
Duque JL, Loughlin KR. An overview of the treatment of superficial bladder cancer: intravesical chemotherapy. Urol Clin North Am. 2000;27:125-134.
Durek C, Brandau S, Ulmer AJ, et al. Bacillus Calmette-Guérin (BCG) and 3D tumors: an in vitro model for the study of adhesion and invasion. J Urol. 1999;162:600-605.
Durek C, Rusch-Gerdes S, Jocham D, et al. Interference of modern antibacterials with bacillus Calmette-Guérin viability. J Urol. 1999;162:1959-1962.
Dutta SC, Smith JAJr, Shappell SB. Clinical under staging of high risk non–muscle-invasive urothelial carcinoma treated with radical cystectomy. J Urol. 2001;166:490-493.
Eichholzer M, Stahelin HB, Gey KF, et al. Prediction of male cancer mortality by plasma levels of interacting vitamins: 17-year follow-up of the prospective Basel study. Int J Cancer. 1996;66:145-150.
Elsasser-Biele U, Leiber C, Wolf P, et al. Adjuvant intravesical treatment of superficial bladder cancer with a standardized mistletoe extract. J Urol. 2005;174:76-79.
Epstein JI, Amin MB, Reuter VR, Mostofi FK. The World Health Organization/International Society of Urological Pathology consensus classification of urothelial (transitional cell) neoplasms of the urinary bladder. Bladder Consensus Conference Committee. Am J Surg Pathol. 1998;22:1435-1448.
Farrow GM, Utz DC, Rife CC. Morphological and clinical observations of patients with early bladder cancer treated with total cystectomy. Cancer Res. 1976;36:2495-2501.
Ficarra V, Dalpiaz O, Alrabi N, et al. Correlation between clinical and pathological staging in a series of radical cystectomies for bladder carcinoma. BJU Int. 2005;95:786-790.
Filbeck T, Pichlmeier U, Knuechel R, et al. Reducing the risk of superficial bladder cancer recurrence with 5-aminolevulinic acid–induced fluorescence diagnosis: results of a 5-year study. Urologe A. 2003;42:1366-1373.
Filbeck T, Roessler W, Knuechel R, et al. 5-Aminolevulinic acid–induced fluorescence endoscopy applied at secondary transurethral resection after conventional resection of primary superficial bladder tumors. Urology. 1999;53:77-81.
Fitzpatrick JM. The natural history of superficial bladder carcinoma. Semin Urol. 1993;11:127-136.
Fitzpatrick JM, West AB, Butler MR, et al. Superficial bladder tumors (stage pTa, grades 1 and 2): the importance of recurrence pattern following initial resection. J Urol. 1986;135:920-922.
Fradet Y, Grossman HB, Gomella L, et al. PC B302/01 Study Group. A comparison of hexaminolevulinate fluorescence cystoscopy and white light cystoscopy for the detection of carcinoma in situ in patients with bladder cancer: a phase III, multicenter study. J Urol. 2007;178(1):68-73.
Freeman JA, Esrig D, Stein JP, et al. Radical cystectomy for high-risk patients with superficial bladder cancer in the era of orthotopic urinary reconstruction. Cancer. 1995;76:833-839.
Frydenberg M, Millar JL, Toner G, et al. Urology Study Committee of the Victorian Co-operative Oncology Group, Cancer Council of Victoria: management of superficial bladder cancer in Victoria: 1990 and 1995. Aust NZ J Surg. 2005;75:270-274.
Fujimoto N, Haradas S, Terado M, et al. Multiple biopsies of normal looking urothelium in patients with superficial bladder cancer: are they necessary? Int J Urol. 2003;10:631-635.
Fukui I, Kihara K, Sekine H, et al. Intravesical combination chemotherapy with mitomycin C and doxorubicin for superficial bladder cancer: a randomized trial of maintenance versus no maintenance following a complete response. Cancer Chemother Pharmacol. 1992;30:37.
Glashan R. A randomized controlled study of intravesical alpha-2b interferon in carcinoma in situ of the bladder. J Urol. 1990;144:658.
Goessl C, Knispel HH, Millar K, Klän R. Is routine excretory urography necessary at first diagnosis of bladder cancer? J Urol. 1997;157:480-481.
Gofrit ON, Shapiro A, Pode D. Combined local bladder hyperthermia and intravesical chemotherapy for the treatment of high-grade superficial bladder cancer. Urology. 2004;63:466-471.
Gohji K, Nomi M, Okamoto M, et al. Conservative therapy for stage T1b, grade 3 transitional cell carcinoma of the bladder. Urology. 1999;53:308-313.
Golin AL, Howard RS. Asymptomatic microscopic hematuria. J Urol. 1980;124:389-391.
Greenberg RE, Bahnson RR, Wood D, et al. Initial report on intravesical administration of N-trifluoroacetyladriamycin-14-valerate (AD-32) to patients with refractory superficial transitional cell carcinoma of the urinary bladder. Urology. 1997;49:471-475.
Grimm MO, Steinhoff C, Simon X, et al. Effect of routine repeat transurethral resection for superficial bladder cancer: a long-term observational study. J Urol. 2003;170:433-437.
Grossfeld GD, Wolf JSJr, Litwan MS, et al. Asymptomatic microscopic hematuria in adults: summary of the AUA best practice policy recommendations. Am Fam Physician. 2001;63:1145-1154.
Grossman HB, Blute ML, Dinney CP, et al. The use of urine-based biomarkers in bladder cancer. Urology. 2006;67(3 Suppl. 1):62-64.
Grossman HB, Liebert M, Antelo M, et al. p53 and RB expression predict progression in T1 bladder cancer. Clin Cancer Res. 1998;4:829-834.
Grossman HB, Messing E, Soloway M, et al. Detection of bladder cancer using a point-of-care proteomic assay. JAMA. 2005;293(7):810-816.
Grossman HB, O’Donnell MA, Cookson MS, et al. Bacillus Calmette-Guérin failures and beyond: contemporary management of non-muscle-invasive bladder cancer. Rev Urol. 2008;10(4):281-289.
Gudjónsson S, Adell L, Merdasa F, et al. Should all patients with non-muscle-invasive bladder cancer receive early intravesical chemotherapy after transurethral resection? The results of a prospective randomised multicentre study. Eur Urol. 2009;55:773-780.
Haaff EO, Catalona WJ, Ratcliffe TL. Detection of interleukin 2 in the urine of patients with superficial bladder tumors after treatment with intravesical BCG. J Urol. 1986;136:970-974.
Haaff EO, Dresner SM, Ratliff TL, et al. Two courses of intravesical bacillus Calmette-Guérin for transitional cell carcinoma of the bladder. J Urol. 1986;136:820-824.
Hall MC, Chang SS, Dalbagni G, et al. Guideline for the management of non-muscle invasive bladder cancer (stages Ta, T1, and Tis): 2007 update. J Urol. 2007;178:2314.
Halling K, King W, Sokolova I, et al. A comparison of cytology and fluorescence in situ hybridization for the detection of urothelial carcinoma. J Urol. 2000;164:1768-1775.
Han RF, Pan JG. Can intravesical bacillus Calmette-Guérin reduce recurrence in patients with superficial bladder cancer? A meta-analysis of randomized trials. Urology. 2006;67:1216-1223.
Harland SJ, Charig CR, Highman W, et al. Outcome in carcinoma in situ of bladder treatment with intravesical bacille Calmette-Guérin. Br J Urol. 1992;70:271.
Harnden P. A critical appraisal of the classification of urothelial tumours: time for a review of the evidence and a radical change? BJU Int. 2007;99(4):723-725.
Hasui Y, Osada Y, Kitada S. Significance of invasion to the muscularis mucosae on the progression of superficial bladder cancer. Urology. 1994;43:782-786.
Haukaas S, Daehlin L, Maartmann-Moe H, et al. The long-term outcome in patients with superficial transitional cell carcinoma of the bladder: a single-institutional experience. BJU Int. 1999;83:957-963.
Hautmann RE, Paiss T. Does the option of the ileal neobladder stimulate patient and physician decision toward earlier cystectomy? J Urol. 1998;159(6):1845-1850.
Hautmann RE, Stein JP. Neobladder with prostatic capsule and seminal-sparing cystectomy for bladder cancer: a step in the wrong direction. Urol Clin North Am. 2005;32:177-185.
Hedelin H, Holmang S, Wiman L. The cost of bladder tumour treatment and follow-up. Scand J Urol Nephrol. 2002;36:344-347.
Heney NM, Ahmed S, Flanagan MJ, et al. Superficial bladder cancer: progression and recurrence. J Urol. 1983;130:1083-1086.
Heney NM, Nocks BN, Daly JJ, et al. Prognostic factors in carcinoma of the ureter. J Urol. 1981;125:632-636.
Heney NM, Proppe K, Prout GR, et al. Invasive bladder cancer: tumor configuration, lymphatic invasion and survival. J Urol. 1983;130:895-897.
Herr HW. Neoadjuvant chemotherapy for invasive bladder cancer. Semin Surg Oncol. 1989;5:266-271.
Herr HW. Tumour progression and survival in patients with T1G3 bladder tumours: 15-year outcome. Br J Urol. 1997;80:762-765.
Herr HW. The value of a second transurethral resection in evaluating patients with bladder tumors. J Urol. 1999;162:74-76.
Herr HW. Tumor progression and survival of patients with high grade, noninvasive papillary (TaG3) bladder tumors: 15-year outcome. J Urol. 2000;163:60-61. discussion 61–62
Herr HW. Timing of a cystectomy for superficial bladder tumors. Urol Oncol. 2000;5:162-165.
Herr HW. Restaging transurethral resection of high risk superficial bladder cancer improves the initial response to bacillus Calmette-Guérin therapy. J Urol. 2005;174:2134-2137.
Herr HW, Badalament RA, Amato DA, et al. Superficial bladder cancer treated with bacillus Calmette-Guérin: a multivariate analysis of factors affecting tumor progression. J Urol. 1989;141:22-29.
Herr HW, Cookson MS, Soloway SM. Upper tract tumors in patients with primary bladder cancer followed for 15 years. J Urol. 1997;156:1286-1287.
Herr HW, Dalbagni G. Defining bacillus Calmette-Guérin refractory superficial bladder tumors. J Urol. 2003;169:1706-1708.
Herr HW, Laudone VP, Badalament RA, et al. Bacillus Calmette-Guérin therapy alters the progression of superficial bladder cancer. J Clin Oncol. 1988;6:1450-1454.
Herr HW, Sogani PC. Does early cystectomy improve the survival of patients with high-risk superficial bladder tumors? J Urol. 2001;166:1296-1299.
Herr HW, Wartinger DD, Fair WR, et al. Bacillus Calmette-Guérin therapy for superficial bladder cancer: a 10-year follow-up. J Urol. 1992;147:1020-1023.
Herranz-Amo F, Diaz-Cordero JM, Verdú-Tartajo F, et al. Need for intravenous urography in patients with primary transitional carcinoma of the bladder? Eur Urol. 1999;36:221-224.
Herts BR. Imaging for renal tumors. Curr Opin Urol. 2003;13:181-186.
Ho KJ, Thompson TJ, O’Brien A, et al. Lignocaine gel: does it cause urethral pain rather than prevent it? Eur Urol. 2003;43:194-196.
Hofstetter A, Kriegman M, Baumgartner R. Evaluation of laser treatment of bladder cancer. In: Smith JAJr, editor. Lasers in urologic surgery. Chicago: Mosby–Year Book; 1994:114-125.
Hollenbeck BK, Taub DA, Miller DC, et al. Quality of care: partial cystectomy for bladder cancer—a case of inappropriate use? J Urol. 2005;174:1050-1054. discussion 1054
Holmang S, Hedelin H, Anderstrom C, et al. The relationship among multiple recurrences, progression and prognosis of patients with stages Ta and T1 transitional cell cancer of the bladder followed for at least 20 years. J Urol. 1995;153:1823-1827.
Holzbeierlein JM, Lopez-Corona E, Bochner BH, et al. Partial cystectomy: a contemporary review of the Memorial Sloan-Kettering Cancer Center experience and recommendations for patient selection. J Urol. 2004;172:878-881.
Holzbeierlein JM, Smith JAJr. Surgical management of noninvasive bladder cancer (stages Ta/T1/CIS). Urol Clin North Am. 2000;27:15-24. vii-viii
Horiguchi Y, Larchian WA, Kaplinsky R, et al. Intravesical liposome-mediated interleukin-2 gene therapy in orthotopic murine bladder cancer model. Gene Ther. 2000;7:844-851.
Horinaga M, Harsch KM, Fukuyama R, et al. Intravesical interleukin-12 gene therapy in an orthotopic bladder cancer model. Urology. 2005;66:461-466.
Hudson MA, Herr HW. Carcinoma in situ of the bladder. J Urol. 1995;153:564-572.
Huguet J, Crego M, Sabate S, et al. Cystectomy in patients with high risk superficial bladder tumors who fail intravesical BCG therapy: pre-cystectomy prostate involvement as a prognostic factor. Eur Urol. 2005;48:53-59.
Huncharek M, McGarry R, Kupelnick B. Impact of intravesical chemotherapy on recurrence rate of recurrent superficial transitional cell carcinoma of the bladder: results of a meta-analysis. Anticancer Res. 2001;21:765-769.
Hurle R, Losa A, Manzetti A, et al. Intravesical bacille Calmette-Guérin in stage T1 grade 3 bladder cancer therapy: a 7-year follow-up. Urology. 1999;54:258-263.
Hurle R, Losa A, Manzetti A, et al. Upper urinary tract tumors developing after treatment of superficial bladder cancer: 7-year follow-up of 591 consecutive patients. Urology. 1999;53:1144-1148.
Hurle R, Losa A, Ranierie A, et al. Low dose Pasteur bacillus Calmette-Guérin regimen in stage T1, grade 3 bladder cancer therapy. J Urol. 1996;156:1602-1605.
Hurle R, Manzetti A, Losa A, et al. Intravesical instillation of mitomycin C in 242 patients with superficial bladder cancer at high risk of recurrence: long-term results. Urol Int. 1998;61:220-226.
Isaka S, Okano T, Abe K, et al. Sequential instillation therapy with mitomycin C and Adriamycin for superficial bladder cancer. Cancer Chemother Pharmacol. 1992;30:41.
Jansson OT, Morcos E, Brundin L, et al. The role of nitric oxide in bacillus Calmette-Guérin mediated anti-tumour effects in human bladder cancer. Br J Cancer. 1998;78:588-592.
Jiang X, Castelao JE, Groshen S, et al. Water intake and bladder cancer risk in Los Angeles County. Int J Cancer. 2008;123(7):1649-1656.
Jichlinski P, Guillou L, Karlsen SJ, et al. Hexyl aminolevulinate fluorescence cystoscopy: new diagnostic tool for photodiagnosis of superficial bladder cancer—a multicenter study. J Urol. 2003;170:226-229.
Jimenez-Cruz JF, Vera-Donoso CD, Leiva O, et al. Intravesical immunoprophylaxis in recurrent superficial bladder cancer (stage T1): multicenter trial comparing bacille Calmette-Guérin and interferon-alpha. Urology. 1997;50:529-535.
Jocham D, Beer M, Baumgartner R, et al. Long-term experience with integral photodynamic therapy of TIS bladder carcinoma. Ciba Foundation Symp. 1989;146:198-205.
Jocham D, Witjes F, Wagner S, et al. Improved detection and treatment of bladder cancer using hexaminolevulinate imaging: a prospective, phase III multicenter study. J Urol. 2005;174:862-866.
Johnson S, Pedersen J, Westman G. Bladder carcinoma—a 20 year review of radical radiation therapy. Radiother Oncol. 1991;22:111-117.
Jones JS. DNA-based molecular cytology for bladder cancer surveillance. Urology. 2006;67(3 Suppl. 1):35-45.
Jones JS, Patel A, Angie M, et al. Office cystoscopy more tolerated with patient visualized real-time video monitoring. Abstract 94765. Presented at the AUA annual meeting, Atlanta, May 20, 2006.
Joudi FN, Smith BJ, O’Donnell MA. Final results from a national multicenter phase II trial of combination bacillus Calmette-Guérin plus interferon alpha-2B for reducing recurrence of superficial bladder cancer. Urol Oncol. 2006;24:344-348.
Joudi FN, Smith BJ, O’Donnell MA, Konetky BR. The impact of age on the response of patients with superficial bladder cancer to intravesical immunotherapy. J Urol. 2006;175:1634-1639.
Jurincic CC, Engelmann U, Gasch J, Klippel KF. Immunotherapy in bladder cancer with keyhole-limpet hemocyanin: a randomized study. J Urol. 1989;139:723-726.
Kalble T, Beer M, Mendoza E, et al. BCG vs. interferon A for prevention of recurrence of superficial bladder cancer: a prospective randomized study. Urologe Ausgabe. 1994;33:133.
Kallioniemi A, Kallioniemi OP, Citro G, et al. Identification of gains and losses of DNA sequences in primary bladder cancer by comparative genomic hybridization. Genes Chromosomes Cancer. 1995;12:213-219.
Kamat AM, DeHaven JI, Lamm DL. Quinolone antibiotics: a potential adjunct to intravesical chemotherapy for bladder cancer. Urology. 1999;54:56-61.
Kamuhabwa A, Agostinis P, Ahmed B, et al. Hypericin as a potential phototherapeutic agent in superficial transitional cell carcinoma of the bladder. Photochem Photobiol Sci. 2004;3(8):772-780.
Kavoussi LR, Torrence RJ, Gillen DP, et al. Results of 6 weekly intravesical BCG instillations on the treatment of superficial bladder tumors. J Urol. 1988;139:935-940.
Kent DL, Shachter R, Sox HC, et al. Efficient scheduling of cystoscopies in monitoring for recurrent bladder cancer. Med Decis Making. 1989;9:26-37.
Khadra MH, Pickard RS, Charlton M, et al. A prospective analysis of 1,930 patients with hematuria to evaluate current diagnostic practice. J Urol. 2000;163:524-527.
Kiemeney LA, Witjes JA, Hiejbroek RP, et al. Should random urothelial biopsies be taken from patients with primary superficial bladder cancer? A decision analysis. Br J Urol. 1994;73:164-171.
Kiemeney LA, Witjes JA, Verbeek AL, et al. The clinical epidemiology of superficial bladder cancer. Dutch South-East Cooperative Urological Group. Br J Cancer. 1993;67:806-812.
Kim HL, Steinberg GD. The current status of bladder preservation in the treatment of muscle invasive bladder cancer. J Urol. 2000;164(3 Pt. 1):627-632.
Kipp BR, Karnes RJ, Brankley SM, et al. Monitoring intravesical therapy for superficial bladder cancer using fluorescence in situ hybridization. J Urol. 2005;173:401-404.
Klan R, Loy V, Huland H. Residual tumor discovered in routine second transurethral resection in patients with stage T1 transitional cell carcinoma of the bladder. J Urol. 1991;146:316-318.
Koch MO, Smith JAJr. Natural history and surgical management of superficial bladder cancer (stages Ta/T1/Tis). In: Vogelzang N, Miles BJ, editors. Comprehensive textbook of genitourinary oncology. Baltimore: Lippincott Williams & Wilkins; 1996:405-415.
Kondylis FI, Demirci S, Ladaga L, et al. Outcomes after intravesical bacillus Calmette-Guérin are not affected by substaging of high grade T1 transitional cell carcinoma. J Urol. 2000;163:1120-1123.
Krege S, Giani G, Meyer R, et al. A randomized multicenter trial of adjuvant therapy in superficial bladder cancer: transurethral resection only versus transurethral resection plus mitomycin C versus transurethral resection plus bacillus Calmette-Guérin. J Urol. 1996;156:962-966.
Kriegmair M, Baumgartner R, Knuchel R, et al. Detection of early bladder cancer by 5-aminolevulinic acid induced porphyrin fluorescence. J Urol. 1996;155:105-110.
Kriegmair M, Baumgartner R, Lumper W, et al. Early clinical experience with 5-aminolevulinic acid for the photodynamic therapy of a superficial bladder cancer. Br J Urol. 1996;77:667-671.
Kriegmair M, Zaak D, Stepp H, et al. Transurethral resection and surveillance of bladder cancer supported by 5-aminolevulinic acid–induced fluorescence endoscopy. Eur Urol. 1999;36:386-392.
Kunju LP, You L, Zhang Y, et al. Lymphovascular invasion of urothelial cancer in matched transurethral bladder tumor resection and radical cystectomy specimens. J Urol. 2008;180(5):1928-1932.
Kurth K, Tunn U, Ay R, et al. Adjuvant chemotherapy for superficial transitional cell bladder carcinoma: long-term results of an EORTC randomized trial comparing doxorubicin, ethoglucid and TUR alone. J Urol. 1997;158:378-384.
Lacome L, Dalbagni G, Zuo-Feng Z, et al. Overexpression of p53 protein in a high risk population of patients with superficial bladder cancer before and after bacillus Calmette-Guérin: correlation to clinical outcome. J Clin Oncol. 1996;14:2646-2652.
Lam JS, Benson MC, O’Donnell MA. Bacillus Calmette-Guérin plus interferon-alpha2B intravesical therapy maintains an extended treatment plan for superficial bladder cancer with minimal toxicity. Urol Oncol. 2003;21:354-360.
Lamm DL, Blumenstein BA, Crawford ED, et al. A randomized trial of intravesical doxorubicin and immunotherapy with bacille Calmette-Guérin for transitional cell carcinoma of the bladder. N Engl J Med. 1991;325:1205-1209.
Lamm DL, Blumenstein BA, Crissman JD, et al. Maintenance bacillus Calmette-Guérin immunotherapy for recurrent Ta,T1 and carcinoma in situ TCC of the bladder: a randomized SWOG study. J Urol. 2000;163:1124-1129.
Lamm DL, Dehaven JI, Riggs DR. Keyhole limpet hemocyanin immunotherapy of bladder cancer: laboratory and clinical studies. Eur Urol. 2000;37(Suppl. 3):41-44.
Lamm DL, Riggs DR. Enhanced immunocompetence by garlic: role in bladder cancer and other malignancies. J Nutr. 2001;131:1067S-1070S.
Lamm DL, Riggs DR, Bugaj M, et al. Prophylaxis in bladder cancer: a meta-analysis. J Urol. 2000;163:151.
Lamm DL, Riggs DR, Shriver JS, et al. Megadose vitamins in bladder cancer: a double-blind clinical trial. J Urol. 1994;151:21-26.
Lamm DL, van der Meijden AD, Morales A, et al. Incidence and treatment of complications of bacillus Calmette-Guérin intravesical therapy in superficial bladder cancer. J Urol. 1992;147:596-600.
Lange N, Jichlinski P, Zellweger M, et al. Photodetection of early human bladder cancer based on the fluorescence of 5-aminolaevulinic acid hexylester-induced protoporphyrin IX: a pilot study. Br J Cancer. 1999;80:185.
Larchian WA, Horiguchi Y, Nair SK, et al. Effectiveness of combined interleukin 2 and B7.1 vaccination strategy is dependent on the sequence and order; a liposome-mediated gene therapy treatment for bladder cancer. Clin Canc Res. 2000;6:2913-2920.
Le Visage C, Rioux-Leclercq N, Haller M, et al. Paclitaxel-loaded gelatin nanoparticles for intravesical bladder cancer therapy. Clin Cancer Res. 2004;10:7677-7684.
LeBlanc B, Duclos AJ, Bernard F, et al. Long-term follow-up of initial Ta grade 1 transitional cell carcinoma of the bladder. J Urol. 1999;162:1946-1950.
Lebret T, Becette V, Burbagelatta M, et al. Correlation between p53 overexpression and response to bacillus Calmette-Guérin therapy in a high risk select population of patients with T1G3 bladder cancer. J Urol. 1998;159:788-791.
Lee CT, Dunn RL, Ingold C, et al. Early-stage bladder cancer surveillance does not improve survival if high-risk patients are permitted to progress to muscle invasion. Urology. 2007;69(6):1068-1072.
Lee LW, Davis EJr. Gross urinary hemorrhage: a symptom, not a disease. JAMA. 1953;153:782-784.
Lerner SP, Sabichi AL, Grossman HB, et al. Results of a randomized chemoprevention trial with fenretinide in non-muscle invasive bladder cancer. Presented at the 2005 American Urological Association Meeting. San Antonio, TX. Abstract #913. J Urol. 2005;173(Suppl.):246.
Liou LS. Urothelial cancer biomarkers for detection and surveillance. Urology. 2006;67(3 Suppl. 1):25-33.
Loidl W, Schmidbauer J, Susani M, Marberger M. Flexible cystoscopy assisted by hexaminolevulinate induced fluorescence: a new approach for bladder cancer detection and surveillance? Eur Urol. 2005;47(3):323-326.
Lokeshwar VB, Habuchi T, Grossman HB, et al. Bladder tumor markers beyond cytology: International Consensus Panel on bladder tumor markers. Urology. 2005;66(6 Suppl. 1):35-63.
Lotan Y, Gupta A, Shariat SF, et al. Lymphovascular invasion is independently associated with overall survival, cause-specific survival, and local and distant recurrence in patients with negative lymph nodes at radical cystectomy. J Clin Oncol. 2005;23:6533-6539.
Luo Y, Chen X, O’Donnell MA. Role of Th1 and Th2 cytokines in BCG-induced IFN-gamma production: cytokine promotion and simulation of BCG effect. Cytokine. 2003;21:17-26.
Lutzeyer W, Rubben H, Dahm H. Prognostic parameters in superficial bladder cancer: an analysis of 215 cases. J Urol. 1982;127:250.
Mack D, Frick J. Five-year results of a phase II study with low-dose bacille Calmette-Guérin therapy in high risk superficial bladder cancer. Urology. 1995;45:958-961.
Malloy TR, Wein A, Shanberg A. Superficial transitional cell carcinoma of the bladder treated with an Nd:YAG laser. J Urol. 1984;131:251.
Malmstrom PU. A randomized comparative dose-ranging study of interferon-alpha and mitomycin-C as an internal control in primary or recurrent superficial transitional cell carcinoma. BJU Int. 2001;89:681-686.
Malmstrom PU, Wijkstrom H, Lundholm C. 5-Year follow-up of a randomized prospective study comparing mitomycin C and bacillus Calmette-Guérin in patients with superficial bladder carcinoma. Swedish-Norwegian Bladder Cancer Study Group. J Urol. 1999;161:1124-1127.
Manoharan M, Soloway MS. Optimal management of the T1G3 bladder cancer. Urol Clin North Am. 2005;32:133-145.
Manyak MJ, Cole JW, Smith PD. Whole bladder photodynamic therapy: enhancement of light distribution from laser optical fibers through the use of diffusion medium. J Urol. 1990;143:81A.
Mao L, Schoenberg MP, Scicchitano M, et al. Molecular detection of primary bladder cancer by microsatellite analysis. Science. 1996;271:659-662.
Martinez-Pineiro JA, Flores N, Isorna S, for CUETO (Club Urologico Espanol de Tratamiento Oncologico). Long-term follow-up of a randomized prospective trial comparing a standard 81 mg dose of intravesical bacille Calmette-Guérin with a reduced dose of 27 mg in superficial bladder cancer. BJU Int. 2002;89:671-680.
Martinez-Pineiro JA, Solsona E, Flores N, et al. Improving the safety of BCG immunotherapy by dose reduction. Eur Urol. 1995;27:13-18.
Masood S, Sriprasad S, Palmer JH. T1G3 bladder cancer—indications for early cystectomy. Int Urol Nephrol. 2004;36:41-44.
May F, Treiber V, Hartung R, Schwaibald H. Significance of random bladder biopsies in superficial bladder cancer. Eur Urol. 2003;44:47-50.
Maymi J, Saltsgaver N, O’Donnell MA. New intravesical sequential chemotherapy for patients with treatment refractory superficial urothelial carcinoma. Poster presentation before the Proceedings of the Society of Urologic Oncology 2004.
McClennan BL, Oertel YC, Malmgren RA, Mendoza M. The effect of water soluble contrast material on urine cytology. Acta Cytol. 1978;22:230-233.
Melekos MD, Chionis H, Pantazakos A, et al. Intravesical bacillus Calmette-Guérin immunoprophylaxis of superficial bladder cancer: results of a controlled prospective trial with modified treatment schedule. J Urol. 1993;149:744-748.
Mersdorf A, Brauers A, Wolff C, et al. Second TUR for superficial bladder cancer: a must? J Urol. 1998;159:143.
Messing EM, Kim K, Wilding G, et al. A randomized prospective phase III trial of difluoromethylornithine (DFMO) vs. placebo (P) in preventing recurrence of completely resected low risk superficial bladder cancer. American Urological Association Annual Meeting 2005. Abstract #922. J Urol. 2005;173(Suppl.):249.
Michaud DS, Spiegelman D, Clinton SK, et al. Fluid intake and the risk of bladder cancer in men. N Engl J Med. 1999;340:1390-1397.
Miki M, Shiozawa H, Matsumoto T, Aizawa T. [Transurethral resection in saline (TURis): a newly developed TUR system preventing obturator nerve reflex.]. Nippon Hinyokika Gakkai Zasshi. 2003;94:671-677.
Miladi M, Peyromaure M, Zerbib M. The value of a second transurethral resection in evaluating patients with bladder tumours. Eur Urol. 2003;43:241-245.
Millan-Rodriguez F, Chechile-Toniolo G, Salvador-Bayarri J, et al. Multivariate analysis of the prognostic factors of primary superficial bladder cancer. J Urol. 2000;163:73-78. 2000
Miller EB, Eure GR, Schellhammer PF. Upper tract transitional cell carcinoma following treatment of superficial bladder cancer with BCG. Urology. 1993;42:26-30.
Mohr DN, Offord KP, Owen RA, et al. Asymptomatic microhematuria and urologic disease: a population-based study. JAMA. 1986;256:224-229.
Morales A, Chin JL, Ramsey EW. Mycobacterial cell wall extract for treatment of carcinoma in situ of the bladder. J Urol. 2001;166:1633-1637. discussion 1637–8
Morales A, Eidinger D, Bruce AW. Intracavitary bacillus Calmette-Guérin in the treatment of superficial bladder tumors. J Urol. 1976;116:180-183.
Morales A, Nickel JA, Wilson JW. Dose-response of bacillus Calmette-Guérin in the treatment of superficial bladder cancer. J Urol. 1992;147:1256-1258.
Morris SB, Gordon EM, Shearer RJ, et al. Superficial bladder cancer: for how long should a tumour-free patient have check cystoscopies? Br J Urol. 1995;75:195-196.
Mufti GR, Singh M. Value of random mucosal biopsies in the management of superficial bladder cancer. Eur Urol. 1992;22:288-293.
Murphy WM, Crabtree WN, Jukkola AF, Soloway MS. The diagnostic value of urine versus bladder washing in patients with bladder cancer. J Urol. 1981;126(3):320-322.
Mydlo JH, Weinstein R, Shah S, et al. Long-term consequences from bladder perforation and/or violation in the presence of transitional cell carcinoma: results of a small series and a review of the literature. J Urol. 1999;161:1128-1132.
Nabi G, Greene D, O’Donnell MO. Suspicious urinary cytology with negative evaluation for malignancy in the diagnostic investigation of haematuria: how to follow up? J Clin Pathol. 2004;57(4):365-368.
Nadler RB, Catalona WJ, Hudson MA, Ratliff TL. Durability of the tumor free response for intravesical BCG therapy. J Urol. 1994;152:367-373.
Naito K, Hisazumi H, Uchibayashi T, et al. Integral laser photodynamic treatment of refractory multifocal bladder tumors. J Urol. 1991;146:1541-1545.
Naitoh J, Franklin J, O’Donnell MA, Belldegrun AS. Interferon alpha for the treatment of superficial bladder cancer. In: Baskin L, Hayward B, editors. Advances in bladder research. New York: Plenum; 1999:371-392.
Newling DW, Robinson MR, Smith PH, et al. Tryptophan metabolites, pyridoxine (vitamin B6), and their influence on the recurrence rate of superficial bladder cancer: results of a prospective, randomized phase III study performed by the EORTC GU Group. Eur Urol. 1995;27:110-116.
Nieder AM, Brausi M, Lamm D, et al. Management of stage T1 tumors of the bladder: International Consensus Panel. Urology. 2005;66(6 Suppl. 1):108-125.
Norming U, Tribukait B, Nyman CR, et al. Prognostic significance of mucosal aneuploidy in stage Ta/T1 grade 3 carcinoma of the bladder. J Urol. 1992;148:1420-1427.
Nseyo UO, DeBord J, Kim H, et al. Sequential whole bladder photodynamic treatments: a preclinical study. Urol Oncol. 1997;3:27-30.
Nseyo UO, DeHaven J, Dougherty TJ, et al. Photodynamic therapy (PDT) in the treatment of patients with resistant superficial bladder cancer: a long-term experience. J Clin Laser Med Surg. 1998;16:61-68.
Oddens JR, van der Meijden AP, Sylvester R. One immediate postoperative instillation of chemotherapy in low risk Ta, T1 bladder cancer patients. Is it always safe? Eur Urol. 2004;46:336-338.
O’Donnell MA. Practical applications of intravesical chemotherapy and immunotherapy in high-risk patients with superficial bladder cancer. Urol Clin North Am. 2005;32:121-131.
O’Donnell MA. Advances in the management of superficial bladder cancer. Semin Oncol. 2007;34:85-97.
O’Donnell MA, Krohn J, DeWolf WC. Salvage intravesical therapy with interferon-alpha-2B plus low dose bacillus Calmette-Guérin is effective in patients with superficial bladder cancer in whom bacillus Calmette-Guérin alone previously failed. J Urol. 2001;166:1300-1305.
O’Donnell MA, Lilli K, Leopold C, National Bacillus Calmette-Guérin/Interferon Phase 2 Investigator Group. Interim results from a national multicenter phase II trial of combination bacillus Calmette-Guérin plus interferon alfa-2b for superficial bladder cancer. J Urol. 2004;172:888-893.
O’Donnell MA, Luo Y, Chen X. Role of IL-12 in the induction and potentiation of IFN gamma in response to BCG. J Immunol. 1999;163:4246-4252.
Oldbring J, Glifberg I, Mikulowski P, et al. Carcinoma of the renal pelvis and ureter following bladder carcinoma: frequency, risk factors and clinicopathological findings. J Urol. 1989;141:1311-1313.
Olsen LH, Genster HG. Prolonging follow-up intervals for non-invasive bladder tumors: a randomized controlled trial. Scand J Urol Nephrol. 1995;172:33-36.
Olsson CA, Chute R, Rao CN. Immunologic reduction of bladder cancer recurrence rate. J Urol. 1974;111:173-176.
Olumi AF, Tsai YC, Nichols PW, et al. Allelic loss of chromosome 17p distinguishes high grade from low-grade transitional cell carcinomas of the bladder. Cancer Res. 1990;50:7081-7083.
Oosterlinck W, Kurth KH, Schroder F, et al. A prospective European Organization for Research and Treatment of Cancer Genitourinary Group randomized trial comparing transurethral resection followed by a single intravesical instillation of epirubicin or water in single state Ta, T1 papillary carcinoma of the bladder. J Urol. 1993;149:749-752.
Orsola A, Palou J, Xavier B, et al. Primary bladder carcinoma in situ: assessment of early BCG response as a prognostic factor. Eur Urol. 1998;33:457-463.
Pagano F, Bassi P, Galetti TP, et al. Results of contemporary radical cystectomy for invasive bladder cancer: a clinicopathological study with an emphasis on the inadequacy of tumor, nodes and metastases classification. J Urol. 1991;145:45.
Pagano F, Bassi P, Milani C, et al. Low dose BCG regimen in superficial bladder cancer therapy: is it effective? J Urol. 1991;146:32-35.
Pagano F, Bassi P, Piazza N, et al. Improving the efficacy of BCG immunotherapy by dose reduction. Eur Urol. 1995;27(Suppl. 1):19-22.
Palit V, Ashurst HN, Biyani CS, et al. Is using lignocaine gel prior to flexible cystoscopy justified? A randomized prospective study. Urol Int. 2003;71:389-392.
Palou J, Farina LA, Villavicencio H, Vicente J. Tumors at the bladder neck may require resection into the prostatic urethra: upper tract urothelial tumor after transurethral resection for bladder tumor. Eur Urol. 1992;21:110-114.
Palou J, Laguna P, Millan-Rodriguez F. Control group and maintenance treatment with bacillus Calmette-Guérin for carcinoma in situ and/or high grade bladder tumors. J Urol. 2001;165(5):1488-1491.
Pansadoro V, Emiliozzi P, Defidio L, et al. Bacillus Calmette-Guérin in the treatment of stage T1 grade 3 transitional cell carcinoma of the bladder: long-term results. J Urol. 1995;154:2054-2058.
Pansadoro V, De Paula F. Intravesical bacillus Calmette-Guérin in the treatment of superficial transitional cell carcinoma of the bladder. J Urol. 1987;138:299-301.
Parmar MKB, Freedman LS, Hargreave TB, et al. Prognostic factors for recurrence and follow-up policies in the treatment of superficial bladder cancer: report from the British Medical Research Council subgroup on superficial bladder cancer (Urological Cancer Working Party). J Urol. 1989;142:284-288.
Patel AR, Jones JS, Angie S, Babineau D. Office based flexible cystoscopy may be less painful for men allowed to view the procedure. J Urol. 2007;177(5):1843-1845.
Patel AR, Jones JS, Babineau D. Impact of real-time visualization of cystoscopy findings on procedural pain in female patients. J Endourol. 2008;22(12):2695-2698.
Patel AR, Jones JS, Babineau D. Lidocaine 2% gel versus plain lubricating gel for pain reduction during flexible cystoscopy: a meta-analysis of prospective, randomized, controlled trials. J Urol. 2008;179(3):986-990.
Patel AR, Larchian WA, Smith AK, et al. Quantification of Sunitinib’s antitumor effects in a localized orthotopic bladder cancer model. J Urol. 2009;181:409.
Peyromaure M, Weibing S, Sebe P, et al. Prognostic value of p53 overexpression in T1G3 bladder tumors treated with bacillus Calmette-Guérin therapy. Urology. 2002;59:409-413.
Platz CE, Cohen MB, Jones MP. Is microstaging of early invasive cancer of the urinary bladder possible or useful? Mod Pathol. 1996;9:1035-1039.
Prout GRJr, Barton BA. 13-cis-Retinoic acid in chemoprevention of superficial bladder cancer. J Cell Biochem. 1992;161:148-152.
Prout GR, Barton BA, Griffin PP, Friedell G. Treated history of noninvasive grade 1 transitional cell carcinoma. J Urol. 1992;148:1413.
Pruthi RS, Baldwin N, Bhalani V, Wallen EM. Conservative management of low risk superficial bladder tumors. J Urol. 2008;179(1):87-90.
Punnen SP, Chin JL, Jewett MAS. Management of bacillus Calmette-Guérin (BCG) refractory superficial bladder cancer: results with intravesical BCG and interferon combination therapy. Can J Urol. 2003;10:1790-1795.
Rajala P, Kaasinen E, Rintala E, et al. Cytostatic effect of different strains of BCG on human bladder cancer cells in vitro alone and in combination with mitomycin C and interferon-alpha. Urol Res. 1992;20:215-221.
Rao PR, Jones JS. Routine perioperative chemotherapy instillation with initial bladder tumor resection: a reconsideration of economic benefits. Cancer. 2009;115:997-1004.
Ratliff TL, Ritchey JK, Brandhorst J, et al. Time-dependent aggregation of reconstituted BCG vaccine. J Urol. 1994;152:2147-2150.
Reading J, Hall RR, Parmar MKB. The application of a prognostic factor analysis for Ta,T1 bladder cancer in routine urological practice. Br J Urol. 1995;75:604-607.
Richter J, Jiang F, Gorog JP, et al. Marked genetic differences between stage pTa and stage pT1 papillary bladder cancer detected by comparative genomic hybridization. Cancer Res. 1997;57:2860-2864.
Riedl CR, Daniltchenko D, Koenig F, et al. Fluorescence endoscopy with 5-aminolevulinic acid reduces early recurrence rate in superficial bladder cancer. J Urol. 2001;165:1121-1123.
Riggs DR, DeHaven JI, Lamb DL. Allium sativum (garlic) treatment for murine transitional cell carcinoma. Cancer. 1997;79:1987-1994.
Rintala E, Jauhiainen K, Kaasinen E, et al. Alternating mitomycin C and bacillus Calmette-Guérin instillation prophylaxis for recurrent papillary (stages Ta to T1) superficial bladder cancer: the Finnbladder Group. J Urol. 1996;156:56.
Rintala E, Jauhiainen K, Rajala P, et al. Alternating mitomycin C and bacillus Calmette-Guérin instillation therapy for carcinoma in situ of the bladder: the Finnbladder Group. J Urol. 1995;154:2050-2053.
Ro JY, Staerkel GA, Ayala AG. Cytologic and histologic features of superficial bladder cancer. Urol Clin North Am. 1992;19:435-453.
Rödel C, Dunst J, Grabenbauer GG, et al. Radiotherapy is an effective treatment for high-risk T1-bladder cancer. Strahlenther Onkol.. 2001;177(2):82-88.
Rodriguez-Rubio F, Sanz G, Garrido S, et al. Patient tolerance during outpatient flexible cystoscopy—a prospective, randomized, double-blind study comparing plain lubrication and lidocaine gel. Scand J Urol Nephrol. 2004;38:477-480.
Rozan R, Albuisson E, Donnarieix D, et al. Interstitial iridium-192 for bladder cancer (a multicentric survey of 205 patients). Int J Radiat Oncol. 1992;24:469-477.
Sadek S, Soloway MS, Hook S, et al. The value of upper tract cytology after transurethral resection of bladder tumor in patients with bladder transitional cell cancer. J Urol. 1999;161:77-80.
Sanchez-Ortiz RF, Huang WC, Mick R. An interval longer than 12 weeks between the diagnosis of muscle invasion and cystectomy is associated with worse outcome in bladder carcinoma. J Urol. 2003;169:110-115. discussion 115
Sarkis AS, Zhang ZF, Cordon-Cardo C, et al. p53 nuclear overexpression and disease progression in Ta bladder carcinoma. Int J Oncol. 1993;3:355.
Sarosdy MF, Lamm DL, Williams R, et al. Phase I trial of oral bropirimine in superficial bladder cancer. J Urol. 1992;147:31.
Sarosdy MF, Schellhammer P, Bokinsky G, et al. Clinical evaluation of a multi-target fluorescent in situ hybridization assay for detection of bladder cancer. J Urol. 2002;168:1950-1954.
Sauter G, Mihatsch MJ. Pussycats and baby tigers: non-invasive (pTa) and minimally invasive (pT1) bladder carcinomas are not the same!. J Pathol. 1998;185:339-341.
Schellhammer PF, Ladaga LE, Fillion MB. Bacillus Calmette-Guérin for superficial transitional cell carcinoma of the bladder. J Urol. 1986;135:261-264.
Schellhammer PF, Ladaga LE, Moriarty RP. Intravesical bacillus Calmette-Guérin for treatment of superficial transitional cell carcinoma of the prostatic urethra in association with carcinoma of the bladder. J Urol. 1995;153:53-56.
Schmidbauer J, Witjes F, Schmeller N, et al. Improved detection of urothelial carcinoma in situ with hexaminolevulinate fluorescence cystoscopy. J Urol. 2004;171:135-138.
Schoenberg M, Paralta C, Kiemeney LA, et al. A contemporary analysis of superficial bladder cancer monitoring: the Johns Hopkins experience. J Urol. 2000;163:152.
Schrag D, Hsieh LJ, Rabbani F, et al. Adherence to surveillance among patients with superficial bladder cancer. J Natl Cancer Inst. 2003;95:588-597.
Schrier BP, Hollander MP, van Rhijn BW, et al. Prognosis of muscle-invasive bladder cancer: difference between primary and progressive tumours and implications for therapy. Eur Urol. 2004;45(3):292-296.
Schwaibold HE, Treiber U, Kuebler H, et al. Second transurethral resection detects histopathological changes worsening the prognosis in 25% of patients with T1 bladder cancer. J Urol. 2000;163:153.
Sekine H, Fukui I, Yamada T. Intravesical mitomycin C and doxorubicin sequential therapy for carcinoma in situ of the bladder: a longer follow-up result. J Urol. 1994;151:27-30.
Shapiro A, Gofrit O, Pode D. The treatment of superficial bladder tumors with IL-2 and BCG. J Urol. 2007;177:244.
Shen Z, Shen T, Wientjes MG, et al. Intravesical treatments of bladder cancer: review. Pharm Res. 2008;25:1500-1510.
Shinka T, Yasunari U, Aoshi H, et al. Occurrence of uroepithelial tumors of the upper urinary tract after the initial diagnosis of bladder cancer. J Urol. 1988;140:745-748.
Shiozawa H, Aizawa T, Ito T, Miki M. A new transurethral resection system: operating in saline environment precludes obturator nerve reflexes. J Urol. 2002;168:2665-2667.
Skacel M, Fahmy M, Brainard JA, et al. Multitarget fluorescence in situ hybridization assay detects transitional cell carcinoma in the majority of patients with bladder cancer and atypical or negative urine cytology. J Urol. 2003;169:2101-2105.
Skolarikos A, Chrisofos M, Ferakis N, et al. Does the management of bladder perforation during transurethral resection of superficial bladder tumors predispose to extravesical tumor recurrence? J Urol. 2005;173:1908-1911.
Smith G, Elton RA, Beynon LL, et al. Prognostic significance of biopsy results of normal looking mucosa in cases of superficial bladder cancer. Br J Urol. 1983;55:665-669.
Smith JA. Treatment of invasive bladder cancer with a neodymium:YAG laser. J Urol. 1986;135:55-57.
Smith JAJr. Endoscopic applications of laser energy. Urol Clin North Am. 1986;13:405-419.
Smith JAJr, Labasky RF, Cockett AT, et al. Bladder cancer clinical guidelines panel summary report on the management of non–muscle-invasive bladder cancer (stages Ta, T1 and TIS). The American Urological Association. J Urol. 1999;162:1697-1701.
Smith JAJr, Landau S. Neodymium:YAG laser specifications for safe intravesical therapy. J Urol. 1989;141:1238-1239.
Soloway MS, Bruck DS, Kim SS. Expectant management of small, recurrent, noninvasive papillary bladder tumors. J Urol. 2003;170:438-441.
Soloway MS, Murphy W, Rao MK, et al. Serial multiple-site biopsies in patients with bladder cancer. J Urol. 1978;120:57-59.
Solsona E, Gonzalez M, Fernandez JM, et al. Random trial comparing intravesical chemo-induction with MMC to BCG vs. intravesical BCG in patients with intermediate-high risk superficial bladder cancer: efficacy evaluation of CUETO trial No 93008. Eur Urol. 2002;1(Suppl. 1):101. abstract 394
Solsona E, Iborra I, Ricos JV, et al. Effectiveness of a single immediate mitomycin C instillation in patients with low risk superficial bladder cancer: short and long-term follow up. J Urol. 1999;161:1120-1123.
Sporn MB, Squire RA, Brown CC, et al. 13-cis-Retinoic acid: inhibition of bladder carcinogenesis in the rat. Science. 1977;195:487-489.
Spruck CH3rd, Ohneseit PF, Gonzalez-Zulueta M, et al. Two molecular pathways to transitional cell carcinoma of the bladder. Cancer Res. 1994;54:744-748.
Stein JP. Indications for early cystectomy. Urology. 2003;62:591-595.
Stein JP, Lieskovsky G, Cote R, et al. Radical cystectomy in the treatment of invasive bladder cancer: long-term results in 1,054 patients. J Clin Oncol. 2001;19:666-675.
Steinberg G, Bahnson R, Brosman S, et al. Efficacy and safety of valrubicin for the treatment of BCG refractory CIS of the bladder. J Urol. 2000;163:761-767.
Steineck G, Hagman U, Gerhardsson M, Norell SE. Vitamin A supplements, fried foods, fat and urothelial cancer: a case-referent study in Stockholm in 1985–87. Int J Cancer. 1990;45:1006-1011.
Steinmaus CM, Nunez S, Smith AH. Diet and bladder cancer: a meta-analysis of six dietary variables. Am J Epidemiol. 2000;151:693-702.
Stricker P, Pryor K, Nicholson T, et al. BCG plus interferon alpha 2b in patients with superficial bladder cancer. Urology. 1996;48:957-962.
Studer UE, Jenzer S, Biedermann C, et al. Adjuvant treatment with a vitamin A analogue (etretinate) after transurethral resection of superficial bladder tumors. Final analysis of a prospective, randomized multicenter trial in Switzerland. Eur Urol. 1995;28:284-290.
Sultana SR, Goodman CM, Byrne DJ, et al. Microscopic hematuria: urological investigation using a standard protocol. Br J Urol. 1996;78:691-698.
Sweatman TW, Parker RF, Isreal M. Pharmacologic rationale for (AD-32): a preclinical study. Cancer Chemother Pharmacol. 1991;28:1.
Swinn MJ, Walker MM, Harbin LJ, et al. Biopsy of the red patch at cystoscopy: is it worthwhile? Eur Urol. 2004;45:471-474.
Sylvester RJ, Oosterlinck W, van der Meijden AP. A single immediate postoperative instillation of chemotherapy decreases the risk of recurrence in patients with stage Ta, T1 bladder cancer: a meta-analysis of published results of randomized clinical trials. J Urol. 2004;171:2186-2190.
Sylvester RJ, van der Meijden A, Witjes JA, et al. High-grade Ta urothelial carcinoma and carcinoma in situ of the bladder. Urology. 2005;66(6 Suppl. 1):90-107.
Sylvester RJ, van der Meijden AP, Lamm DL. Intravesical bacillus Calmette-Guérin reduces the risk of progression in patients with superficial bladder cancer: a meta-analysis of the published results of randomized clinical trials. J Urol. 2002;168:1964-1970.
Têtu B, Tiguert R, Harel F, Fradet Y. ImmunoCyt/uCyt+ improves the sensitivity of urine cytology in patients followed for urothelial carcinoma. Mod Pathol. 2005;18(1):83-89.
Thompson RA, Campbell EW, Kramer HC, et al. Late invasive recurrence despite long-term surveillance for superficial bladder cancer. J Urol. 1993;149:1010-1011.
Thrasher JB, Crawford ED. Complications of intravesical chemotherapy. Urol Clin North Am. 1992;19:529.
Tissot WD, Diokno AC, Peters KM. A referral center’s experience with transitional cell carcinoma misdiagnosed as interstitial cystitis. J Urol. 2004;172:478-480.
Tolley DA, Parmar MK, Grigor KM, et al. The effect of intravesical mitomycin C on recurrence of newly diagnosed superficial bladder cancer: a further report with 7 years of follow-up. J Urol. 1996;155:1233.
Toma MI, Friedrich MG, Hautmann SH, et al. Comparison of the ImmunoCyt test and urinary cytology with other urine tests in the detection and surveillance of bladder cancer. World J Urol. 2004;22(2):145-149.
Torti FM, Shortliffe LD, Williams RD. Alpha-interferon in superficial bladder cancer: a Northern California Oncology Group Study. J Clin Oncol. 1988;6:476-483.
Tsivian A, Shtricker A, Sidi AA. Simultaneous transurethral resection of bladder tumor and benign prostatic hyperplasia: hazardous or a safe timesaver? J Urol. 2003;170(6 Pt. 1):2241-2243.
Uchibayashi T, Koshida K, Kunimi K, et al. Whole bladder wall photodynamic therapy for refractory carcinoma in situ of the bladder. Br J Cancer. 1995;71:628.
van der Heijden AG, Kiemeney LA, Gofrit ON, et al. Preliminary European results of local microwave hyperthermia and chemotherapy treatment in intermediate or high risk superficial transitional cell carcinoma of the bladder. Eur Urol. 2004;46:65-71.
van der Meijden AP, Hall RR, Macaluso P, et al. Marker tumour response to the sequential combination of intravesical therapy with mitomycin-C and BCG-RIVM in multiple superficial bladder tumours. Eur Urol. 1996;29:199-201.
van der Meijden AP, Oosterlinck W, Brausi M, et al. Significance of bladder biopsies in Ta,T1 bladder tumors: a report from the EORTC Genito-Urinary Tract Cancer Cooperative Group. EORTC-GU Group Superficial Bladder Committee. Eur Urol. 1999;35:267-271.
Varkarakis MJ, Gaeta J, Moore RH, et al. Superficial bladder tumor: aspects of clinical progression. Urology. 1974;4:414-420.
Vogeli TA, Grimm MO, Ackermann R. Prospective study for quality control of TUR of bladder tumors by routine second TUR (ReTUR). J Urol. 1998;159:143.
Waldman FM, Carroll PR, Kerschmann R, et al. Centromeric copy number of chromosome 7 is strongly correlated with tumor grade and labeling index in human bladder cancer. Cancer Res. 1991;51:3807-3813.
Walther MM. The role of photodynamic therapy in the treatment of recurrent superficial bladder cancer. Urol Clin North Am. 2000;27:163-170.
Whitson J, Berry A, Carroll P, Konety B. A multicolour fluorescence in situ hybridization test predicts recurrence in patients with high-risk superficial bladder tumours undergoing intravesical therapy. BJU Int. 2009;104:336-339.
Witjes JA, Caris CT, Mungan NA, et al. Results of a randomized phase III trial of sequential intravesical therapy with mitomycin C and bacillus Calmette-Guérin versus mitomycin alone in patients with superficial bladder cancer. J Urol. 1998;160:1668-1672.
Witjes JA, Hendricksen K. Intravesical pharmacotherapy for non-muscle-invasive bladder cancer: a critical analysis of currently available drugs, treatment schedules, and long-term results. Eur Urol. 2008;53(1):45-52.
Witjes JA, Moonen PM, van der Heijden AG. Comparison of hexaminolevulinate based flexible and rigid fluorescence cystoscopy with rigid white light cystoscopy in bladder cancer: results of a prospective Phase II study. Eur Urol. 2005;47(3):319-322.
Wright JL, Hotaling J, Porter MP. Predictors of upper tract urothelial cell carcinoma after primary bladder cancer: a population based analysis. J Urol. 2009;181(3):1035-1039.
Yamada Y, Hayashi Y, Kohri K, et al. Random biopsy and recurrence risk in patients with bladder cancer. Jpn J Urol. 1996;87:61-66.
Yoder BJ, Skacel M, Hedgepeth R, et al. Reflex UroVysion testing of bladder cancer surveillance patients with equivocal or negative urine cytology: a prospective study with focus on the natural history of anticipatory positive findings. Am J Clin Pathol. 2007;127(2):295-301.
Younes M, Sussman J, True LD. The usefulness of the level of the muscularis mucosae in the staging of invasive transitional cell carcinoma of the urinary bladder. Cancer. 1990;66:543-548.
Zieger K, Wolf H, Olsen PR, et al. Long-term follow-up of noninvasive bladder tumours (stage Ta): recurrence and progression. BJU Int. 2000;85:824-828.
Zincke H, Utz DC, Farrow GM. Review of Mayo Clinic experience with carcinoma in situ. Urology. 1985;26:39-46.
Zincke H, Utz DC, Taylor WF, et al. Influence of thiotepa and doxorubicin instillation at time of transurethral surgical treatment of bladder cancer on tumor recurrence: a prospective, randomized double blind, controlled trial. J Urol. 1983;129:505.